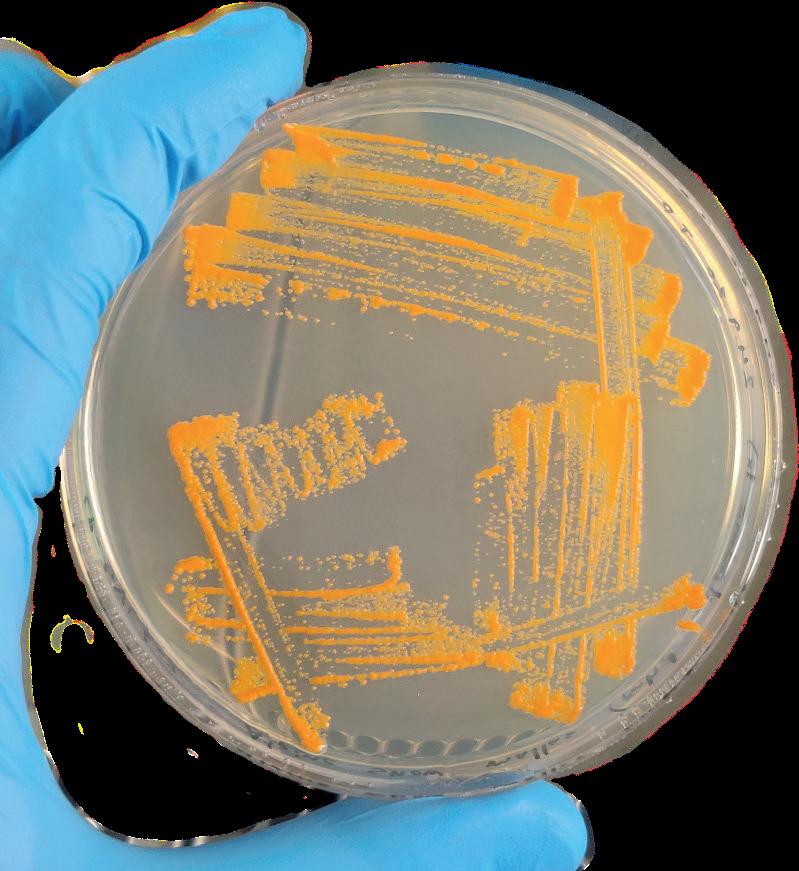

ALKIO

johdatus
biologian ja molekyylibiotieteiden opetukseen 2024
![]()

johdatus
biologian ja molekyylibiotieteiden opetukseen 2024
johdatus



Toimitus ja taitto
Oona Kurola
Essi Kumpumäki
Suvi Leskinen (vastaava toimittaja)
Etukansi
Suvi Leskinen
Täällä kirjoittavat Symbioosin ja Helixin puheenjohtajat Kiisla ja Ella. Paljon onnea jokaiselle opiskelupaikasta ja tervetuloa iki-ihanalle Viikin kampukselle! Tunnelma voi vielä olla vähän sekava ja päässä monen monta kysymystä, mutta ei hätää, ette ole asian kanssa yksin. Jotta yliopiston aloittaminen olisi edes hippusen vähemmän sekavaa, on teitä varten koottu kompaktiksi infopaketiksi tämä opus, Alkio, jonka avulla pääset perille tärkeimmistä asioista biologian tai molekyylibiologian kandiohjelmissa opiskelusta. Opiskeluun liittyvien asioiden lisäksi haluamme tutustuttaa teidät ainejärjestöihimme, Symbioosiin ja Helixiin. Meidän tapahtumiimme olette kaikki tervetulleita ja kannustamme, että lähdette mukaan matalalla kynnyksellä. Tapahtumien kirjo on laaja, joten jokaiselle löytyy varmasti omannäköistä puuhaa. Ohjelmistosta löytyy bileitä, luontoretkiä, yritys- ja liikunta-excursioita, sitsejä ja sekä rentoja kertsihengauksia. Kannustamme myös lähtemään mukaan ainejärjestötoimijoiksi, sillä luonnollisesti monipuolisten tapahtumien tarjoamiseksi tarvitaan järjestäjiksi myös monenlaisia, eri asioista kiinnostuneita ihmisiä. Ja jos mielestäsi tapahtumakattauksesta puuttuu jotain, ainejärjestötoimijana pääset ideoimaan ja järjestämään tapahtumia ihan itse!
Alta löydät meistä puheenjohtajista pienet esittelytekstit! Muistakaa, että meille, muille ainejärjestötoimijoille ja tietysti tuutoreille saa ehdottomasti tulla juttelemaan tai kysymään mieltä askarruttavista asioista! Ihanaa syksyä ja tsemppiä yliopiston alkuun <3
Moi! Olen Kiisla ja opiskelen kolmatta vuotta biologian kandiohjelmassa, jossa suuntaudun genetiikkaan. Vaikka oman fuksivuoden aloituksesta on jo ehtinyt pari vuotta vierähtää, ovat siihen liittyvät tunteet edelleen hyvin muistettavissa. Yliopiston aloitus oli hyvin jännittävää, enkä ollut ollenkaan varma löytäisinkö sieltä oman paikkani. Aikani Viikissä on kuitenkin tähän mennessä ollut tapahtumarikas ja ihana. En olisi missään nimessä kaksi vuotta sitten Alkiota selatessani uskonut, että kirjoittaisin tänne pian itse Symbioosi ry:n puheenjohtajan roolissa. Niin siinä vain kävi! Yliopiston ja ainejärjestöjuttujen kautta voi päätyä mitä yllättävimpiin tilanteisiin ja löytää itsestään uusia puolia. Mikä tärkeintä, sen avulla voi tutustua upeisiin ihmisiin ja saada elämänmittaisia ystäviä. Siksi toivon jokaiselle rohkeutta mennä ja tutustua eri järjestöjen tapahtumiin ja toimintaan. Kaikkein parasta on, kun löytää juuri itselleen sopivan yhteisön. Muistakaa ottaa opiskeluajasta ja fuksivuodesta kaikki irti!
Ihanaa syksyä. Viikissä törmäillään!
Kiisla, Symbioosin puheenjohtaja

Hei! Olen Ella, Helixin puheenjohtaja ja aloitan syksyllä opinnot (maisteri)fuksina. Valmistuin siis molekyylibiotieteiden kandiksi noin kuukausi sitten ja on pakko sanoa, että valmistuminen on varmasti tylsin asia mitä olen yliopistossa saanut kokea. Toki moni (itseni mukaan lukien) aloittaa yliopistouran suunnitelmana opiskella ja ehkä jopa valmistua. On kuitenkin vaikea kuvailla miten paljon “opiskelijaelämässä” voi oppia kaiken muun kuin itse opiskelun parissa, jos avaatte mielenne ja sydämenne mahdollisuuksille, joita Viikki tulee teille tarjoamaan.
Siis tervetuloa Viikkiin tutustumaan tulevaisuutenne tärkeimpiin ihmisiin, juhlimaan, temmeltämään, nauramaan, itkemään, iloitsemaan ja kaiken lisäksi opiskelemaan. Minut voitte usein löytää Biokeskus 1:n kerhohuoneelta tekemästä milloin mitäkin edellä mainituista aktiviteeteista. Tulkaa ihmeessä juttelemaan, jos teillä on jotain mielenpäällä, mieluusti vaikkei olisikaan. Otan vastaan kaikki saatavilla olevat huvitukset ja häiriöntekijät vältellessäni vastuitani.
Loistavaa syksyä kaikille ja onnea opintoihin!
Ella, Helixin puheenjohtaja

Helsingin yliopiston hallinto ja opetusjärjestelyt jakaantuvat tieteenalojen mukaan jaettuihin 11 suureen yksikköön, tiedekuntaan. Lisäksi yliopistolla on useita erillisyksiköitä, joista osa antaa opetusta. Yliopisto on keskittänyt toimintansa neljälle kampukselle. Tämä artikkeli antaa sinulle joitain perustietoja uudesta opinahjostasi. Tekstin tarkoitus on antaa sinulle käsitys siitä, mihin sijoitut yliopiston hallinnollisella kartalla ja ketkä tekevät sinua koskevia päätöksiä.
Yliopisto
”Yliopiston tehtävät ovat tutkimus, opetus ja sitä tukeva yhteiskunnallinen vuorovaikutus.” Yliopisto on sivistyksen ja uuden tiedon kehto, jossa opetuskin perustuu tutkimukseen, ja uusin tieto ja tutkimusmenetelmät ovat esillä kauan, ennen kuin niistä kirjoitetaan Helsingin Sanomissa. Yliopistoa johtavat rehtori, vararehtorit ja yksiköiden johtajat.
Rehtori johtaa yliopiston toimintaa ja vastaa yliopiston tehtävien tuloksellisesta, taloudellisesta ja tehokkaasta hoitamisesta. Yliopiston rehtorina toimii psykologi ja yliopistopedagogiikan professori Sari Lindblom
Helsingin yliopiston kanslerin tehtävänä on edistää tieteitä ja yliopiston yhteiskunnallista vuorovaikutusta sekä valvoa yliopiston yleistä etua ja toimintaa. Kansleri myöntää professorin arvonimen ja dosentin arvon sekä luvan promootioiden järjestämiseen. Tällä hetkellä kanslerina toimii Kaarle Hämeri.

Helsingin yliopiston tiedekunnat Bio- ja ympäristötieteellinen Farmasia
Eläinlääketieteellinen Humanistinen Kasvatustieteellinen
Lääketieteellinen
Maatalous-metsätieteellinen
Matemaattis-luonnontieteellinen Oikeustieteellinen
Teologinen
Valtiotieteellinen
Yliopiston korkein päättävä elin on yliopiston hallitus, joka muodostuu eri tiedekuntien jäsenistä kandidaateista professoreihin.
Dekaani = tiedekunnan pomo
Tiedekunta
Tiedekuntaa johtaa dekaani yhdessä varadekaanien kanssa. Bio- ja ympäristötieteellisen tiedekunnan dekaanin virassa toistaiseksi toimii neurotieteen professori Juha Voipio. Dekaani ja varadekaanit valvovat ja vastaavat tutkimuksesta ja opetuksesta.
Tiedekunnan korkein päättävä elin on tiedekuntaneuvosto: 11 jäsenen hallinnollinen toimielin, joka kehittää tiedekunnan toimintaa dekaanin johdolla. Tiedekuntaneuvostoon kuuluu dekaanin lisäksi professoreita, opettajia, muuta opetushenkilökuntaa sekä opiskelijoita. Tiedekuntaneuvosto tekee kaikki tiedekunnan suuret päätökset, joista opiskelijajäsenillä on tapana tiedottaa Facebookin Bio- ja ympäristötieteellisen opintoasiat -ryhmässä. Tähän ryhmään siis kannattaa liittyä. Tiedekuntaneuvoston pöytäkirjat ovat myös luettavissa yliopiston tiedotusportaali Flammassa.
Toimikunnat
Tiedekunnan päätöksenteon valmistelua varten ovat tiedekunnassa dekaanin asettamat toimikunnat – koulutusohjelmatoimikunta, tutkimusohjelmatoimikunta ja yhteiskuntasuhteiden toimikunta – sekä tiedekuntaneuvoston asettama opetustaitotoimikunta.
Koulutusohjelmatoimikunta vastaa opintoasioihin kuten tutkintorakenteisiin liittyvästä suunnittelusta ja valmistelusta. Koulutusohjelmatoimikuntaan kuuluu myös opiskelijajäseniä. Opiskelijajäsenet nimetään kahdeksi vuodeksi kerrallaan. Nykyiset opiskelijajäsenet jatkavat 31.12.2024 asti.
Koulutusohjelmatoimikunnan lisäksi jokaista koulutusohjelmaa, mm. biologiaa ja molekyylibiotieteitä, valvoo oma johtoryhmä.
Tutkimusohjelmatoimikunta vastaa tutkimukseen ja tohtorikoulutukseen liittyvästä val-
mistelusta ja valvomisesta. Tähän toimikuntaan ei kuulu perustutkinto-opiskelijoita, mutta tohtorikoulutettavia kylläkin. Bio- ja ympäristötieteellisen tiedekunnan viralliset tutkimusohjelmat ovat Ekosysteemit ja ympäristö, Organismi- ja evoluutiobiologia sekä Molekulaariset ja integratiiviset biotieteet.
Yhteiskuntasuhteiden toimikunnan tehtävä on tukea ja suunnitella tiedekunnan yhteiskunnallisen vuorovaikutustoiminnan vaikuttavuutta esimerkiksi yritysyhteistyössä sekä varainhankinnassa.
Opetustaitotoimikunnan tehtävänä on edistää tiedekunnan opetus- ja tutkimushenkilöstön opetustaidon kehittämistä. Toimikunnassa on professoreiden, muun opetus- ja tutkimushenkilöstön sekä opiskelijoiden edustus.
Opiskelijat hallinnon jäseninä
Kuten edellä tuli esille, opiskelijakin voi päästä mukaan yliopiston hallintoon. Hallinnon opiskelijajäseniä kutsutaan hallopedeiksi. Opiskelijajäsenen paikkaa kannattaa rohkeasti hakea, kunhan hakuaika jälleen tulee kohdalle.
Jos haluat maksimoida mahdollisuutesi tulla haussa valituksi tai muuten vain et jaksa odotella uuden toimikauden alkua, pääset hankkimaan tietämystä tiedekunnan hallinnosta myös opiskelijajärjestön opintovastaavan roolissa. Viikin opiskelijajärjestöjä ovat Biosfääri, MMYL, Symbioosi, SvNK, Helix ja Myy – näistä lisää tulevilla sivuilla!
Halloped(i) = hallinnon opiskelijaedustaja


Kartan paikat ja symbolit
1. Biokeskus 1
2. Biokeskus 2
3. Biokeskus 3
4. Metsätieteiden talo
5. EE-talo
6. Eläinsairaala
7. Viikin tutkimustila
8. CoolHead Brew
9. Prisma (myös apteekki ym.)







Lisää Viikin kampuksesta
Viikin kampuksen esittely
Rakennusten luentosalit ja yhteystiedot
Ruokalat
UniCafe
Sodexo Ravintola Ladonlukko
Julkinen liikenne
Helsingin seudun liikenne (HSL)
Infokeskus Korona, kirjasto
Ruokala
Bussipysäkki
Pikaratikka
Kaupunkipyörä (kausi huhti-lokakuu)
Parkkipaikka

Opinnotalkamassajatermithukassa?Tärkeääonosataomanalansa keskeisimmättermit,muttamyösopiskelijaelämäänliitännäiset sanatjaasiat.Eihuoltafuksi,tässäkompaktipakettiainakinosasta keskeisimmistäopiskelijäelämästäselviämiseentarvittavasta termeistäavuksesi.Javaikkaeivätkaikkijäisikäänmieleenniin tekemälläoppiiijakysyväeitieltäeksy,vaimitensemeni…
Yliopistoayleisesti
Fuksi =1.vuodenopiskelija
Lipasto =Puhekielessäjoskusesiintyvälyhenneyliopistosta.
Noppa =Opintopiste
Akateeminenvartti =Kaikkiluennotyleensäalkavat15ylieikäesim. tasaltaelleimuutenmainita.Tätäkutsutaanakateemiseksivartiksi.
Unari =UnicafeeliYLVA:nhallinnoimaopiskelijaravintola,jostasaa ostettualounastajaruokaahulppeaanopiskelijahintaan.
YLVA =EntinenHYY-yhtymä.HYY:nomistamakonserni,jokavastaa HYY:nliiketoiminnasta(mm.ravintoloitajakiinteistöjä).
Akvaario =Examinarium-tenttitila,jossavoikäydätekemässätentin tietokoneellavarattuunaikaan.Eiolevalvojaaläsnä,muttatallentava videovalvonta.
Sisu =Opintojenseuraamistajakursseilleilmottautumistavartentehty järjestelmä
Moodle =Oppimisympäristö,jonnetulevatkurssientiedotjamateriaalit. Tehtävienteko,esseidenpalautusjatenttiminenonmahdollistaMoodlessa.



Ainejärjestö =Tietynalantaioppiaineenopiskelijoidenmuodostama yhdistys,jokamuunmuassavalvoojaedistääopiskelijoidenoikeuksiaja järjestääerinäisiätapahtumia.
Tiedekuntajärjestö =Opiskelijoidenmuodostamakokotiedekuntaa edustavayhdistys.Ainejärjestötovattiedekuntajärjestöjenjäseniä. Ainejärjestöihinverrattunatiedekuntajärjestöjenroolionyleensälaajaalaisempi.
Kattojärjestö =“Hierarkiassa”ylempänätoimivajärjestö,esim. tiedekuntajärjestöonainejärjestönkattojärjestö
HYY =HelsinginYliopistonYlioppilaskunta.Opiskelijayhteisönylinelin, jokaomistaamm.YLVA:njajonkapiirissämelkeinkaikkijärjestöttoimivat. Opiskelijoidenaktiivinenedunvalvoja,jonkarakennemuistuttaavaltion hallintoa:HYY:llaonhallitusjaedustajisto,joistamolemmatkoostuvat opiskelijoista.HYY:llaonmyösuseitaerilaisiavaliokuntia(Ympäristövaliokunta,Kehitysyhteistyövaliokunta,Tapahtumavaliokunta…),joiden toimintaanvoihakeutuamukaan.
Edustajisto-eliedarivaalit:HYY:nedustajistovalitaankahdenvuoden väleinvaaleilla,joissajokainenHYY:njäsenonäänioikeutettu.Kukatahansa voiasettuaehdollevaalipiirienkautta.Eduskunnantapaanedustajistollaon ylinpäätösvalta.
Osakunta =Helsinginyliopistonpiirissätoimiviaopiskelijayhteisöjä,jotka keräävätyhteenopiskelijoitapoikkitieteellisestierialueilta(esim. Pohjalaisosakunnat,Savolaisosakunta,Hämäläisosakunta…)
Hallitus =Järjestöihinvalitaankalenterivuosittainhallitus,jokapäättää ainejärjestönasioista.Hallitukseenvoiliittyäkukatahansajärjestön varsinainenjäsen.Aktiivisestaosallistumisestavoimyöshakeatiedekunnalta opintopisteitä.
Virkailija =Järjestöntoimihenkilö,jokaeikuuluhallitukseen.Järjestöistä löytyyerilaisiavirkojaainatapahtumatiimistäliikunta-jatyöelämävastaaviin. Lisätietoaviroistalöytyyjärjestöjenverkkosivuilta.
Eritiedostuskanavat =Järjestöjentiedotustapahtuusähköpostilistojen, somenjakeskusteluryhmienkautta.Jokaisellajärjestölläonoma sähköpostilistansa,johonliittymisestälöytyylisätietojajärjestön verkkosivuilta.Facebookissajärjestöilläonomasivunsajaryhmänsä. Aktiivinentiedotustapahtuufb-ryhmässä.Järjestöjeninstagram-tilitkannattaa myösottaaaktiiviseenseurantaan,sitäkauttasaahelpostitietoatulevista tapahtumistajayms.Keskustelukanavat,kutenvirallisetTelegram-ryhmätovat tiedotuksenlisäksialustojaihanvaanpaskanpuhumisellejaerilaistenasioiden kyselemiselle.

Sitsit =Akateeminenpöytäjuhla.Normaalejabileitähienostuneemmatjuhlat, joissalauletaansitsilaulujalaulunjohtajienjohdolla,syödäänjajuodaan. Kultainensitsiohjelöytyylaulukirjastajajaetaanosallistujilleennen tapahtumaa.Myöslaulunjohtajatkertaavatsitsiensääntöjäjasitsisanastoa. Vaikkasitsitkuulostavatkinvirallisilta,ovatnesiltihyvinrentotapahtuma.
Laulukirja =Järjestöilläonomatlaulukirjansa,joistalöytyysitseillä laulettavialauluja.Osalauluistaonperinteisiäkokoyliopistossatunnettuja lauluja,osataasonhyvinspesifejäjärjestöille.Laulukirjanvoiostaa järjestöltä,janiitäkierrätetäänsitseilläpöydissämuilleerinäistenterveisten kirjoittamistavarten.Laulukirjaonsiismyöskivamuistokäydyistäsitseistä.
Läsy =Läsyelilaululäsyonpaperinentaisähköinenvihkonen,johonon kerättyyleisimpiälauluja.Läsyvoidaantehdätapahtumakohtaisestiesim. järjestöjenyhteissitseille,joissakaikkilauluteivätlöydykaikkien laulukirjoista.
Vujutelivuosijuhlat =Opiskelijajärjestöjenjaosakuntienhienoimmat akateemisetjuhlat.Vujutovatperusrakenteeltaansamanlaisetkuinsitsit,mutta tapahtumaonjuhlallisempijamuodollisempi,jasisältääpaljonesim.puheita.
BYTDK:njärjestötjärjestävätvuosijuhlatviidenvuodenvälein.
Konjakkikorvat =Vuosijuhlienloppupuolellalautasliinoistataiteltava päähine.
Approt =Opiskelijatapahtuma,jokakoostuuyleensäerinäistenrastien kiertelystätaisuunnistustyyppisestäbaarienkiertelystä,jossasaa opiskelijahintaanvirvokkeita.Eritasotns.tutkintotasot,suorituksenmukaan, jostayleensäsaasitävastaavanhaalarimerkin.
BD-pelit =Biodiversiteetti-peliteliSymbioosiry:njärjestämätBio-ja ympäristötieteellisentiedekunnanfuksiaiset:Fuksitkiertävättuutoreidensa kanssaryhmissähauskastipukeutuneenaerinäisiärastejajaparhaiten suoriutunuttiimipalkitaan.
Excursioeliexcu =Tapahtuma,jokaonreissujohonkinkohteeseen.Excu voikohdistuaesim.kulttuuritapahtumiin,yrityksiintaimuihin mielenkiintoisiinpaikkoihin.
KideApp =Sovellus,jostavoiostaaopiskelijatapahtumiinlippujajasieltä löytyymyösinfoatapahtumistaympärimaata.


Uusi =Uusiylioppilastalo,HYY:nomistamakiinteistöHelsinginkeskustassa Mannerheimintiellä.
Vanha =Vanhaylioppilastalo,HYY:nomistamakiinteistöHelsingin keskustassaMannerheimintiellä.
Klusteri =KlusterieliklusseonHYY:nomistamajärjestötila.
Pupu =Pupu-klusterieliHeddaGableronEtu-Töölössäosoitteessa Mechelininkatu3DsijaitsevaHYY:ntila,jonkajakaauseampijärjestö(mm. Helix,MYY,MMYL,Viikki-speksi…)
Matlu-klusse =ViralliseltanimeltäänChristinaRegina.Matlu-klusteri sijaitseeEtu-TöölössäHYY:nomistamassaDomusGaudium-rakennuksessa osoitteessaLeppäsuonkatu11.Matlu-klusterinjakaauseampijärjestö,mm. SymbioosijaSymbioosinkuoro.
Pesä =Käärmeenpesä,YFK:n(Yliopistonfarmasiakunta)omistama vuokrattavajuhlatilaSörnäisissä.
Eufa =Euphoria,LKS:n(Lääketieteenkandidaattiseura)omistama vuokrattavajuhlatilaSörnäisissä.
Grundi =SanallaviitataanyleensäC-grundiin,jokaonLatokartanon ylioppilaskylänomistamaViikissäsijaitsevajuhlatila,jotajärjestötvoivat vuokrata.
Alina-sali =HYY:njuhlatilaUudellaylioppilastalolla.Järjestötsaavat varataAlina-salinkäyttöönsäyleensäkaksikertaalukukaudessa.Alinassa järjestetäänuseinsitsejä.
Sivistys =KattosaunaSivistys.HYY:nomistamasaunatilaDomus Gaudiuminylimmässäkerroksessa,jotajärjestötvoivatvaratakäyttöönsä.
Niemi =Otaniemi
Kursseja,opintopisteitä,seminaareja...Siismitäihmettä?Vastuu opintojensuunnittelustaonnytsinulla,muttaonneksiapuaon saatavilla.Vanhemmatopiskelijat,tuutoritjaopinto-ohjaajatauttavat omanopintopolunlöytämisessäjaHOPSin(henkilökohtainenopintosuunnitelma)tekemisessä.Omienopintojensuunnittelukannattaa aloittaaopinto-oppaanselaamisesta,jatietenkintästätietopaketista.
Aloitetaansiisperusasioista.Akateeminenvuosielilukuvuosialkaa useimmitensyyskuunalussaja päättyytoukokuussa.Vuosijakautuu neljäänperiodiin,joistaperioditIja IIedustavatsyyslukukauttajaperioditIIIjaIVkevätlukukautta.Jokaisenperiodinvälissäonniinkutsuttu tentti-jalukuviikko,jolloineijärjestetäjuurikaanluento-opetusta.Tiedekunnassammetosinperiodienrajat saattavatollatoisinaanhiemanhäilyviä.
Yliopistonperustutkinnoissaon käytössäkaksiportainentutkintorakenne.Tämätarkoittaasiissitä,että ensinsuoritetaankandidaatintutkinto,jonkalaajuuson180opintopistettäjatämänjälkeen120opintopisteenmaisterintutkinto.Useinsekä kandiettämaisterisuoritetaan samassayliopistossajatiedekunnassa,muttakaksiportaisuusmahdollistaamaisterinsuorittamisen myösmuualla,vaikkapaulkomailla. Opintojenedistymistämitataan opintopisteillä,tuttavallisemminnopilla.
Virallisenmääritelmänmukaanyksi opintopistevastaanoin27tuntia töitä.Suositeltuopintojenetenemistahtion60opintopistettävuodessa, mikävastaamelkotarkastikokoaikaistavuosityöaikaa.Tuletkuitenkin huomaamaan,ettäopintopisteisiin vaadittavattyömäärävaihteleehyvinkinpaljonerikurssienvälillä.
Tutkintoonkuuluupääaineesiperusjaaineopinnotsekäpakollisettukiaineet,kutentilastotiede,jakielten kursseja.Aiemmissatutkintorakenteissaolivaatimuksenasivuainekokonaisuus,muttanykyääntätä vaatimustaeienääole.Tutkintoon sisältyykuitenkintiettymäärä vapaavalintaisiaopintoja,muttavoit valitanenykyäänvapaastimistä tahansaoppiaineista,jotkasinua kiinnostavat.
Maisterintutkinnossaopinnotmuodostuvatpääaineensyventävistä opinnoista(pakollisetjavapaavalintaiset)sekämuistaopinnoista.Maisteriopinnotpäättää30opintopisteen progradu-tutkielmaeligradu.
Termistönjabyrokratiankeskelläpujotteluvoi välillävetäänaamantähänilmeeseen.Älä kuitenkaanlannistu:etoleongelmienkanssa yksin!


Kandi-taimaisterivaiheessavoit hakeavaihto-opintoihinulkomaille taiJOO-elijoustavanopintooikeudenopintoihintoiseensuomalaiseenyliopistoon.Kumpaakin vaihtoehtoakannattaasuunnitella hyvissäajoinetukäteen.
Opintojensuoritusaikaonrajattu yliopistossaseitsemäänvuoteen.Jos opintosikestävätpidempään,joudut hakemaanlisäaikaaopintojensuorittamiseen.Välivuosiavoipitääyliopistossavainharvoistasyistä,joihin lukeutuvatesimerkiksivarusmies-ja siviilipalvelus.
Hyvä!Nytsinullaonhallussasi perusasiat!Seuraavaksilyhytsyventyminen...
SaadaksesiKelaltaopintotukeasinun onsuoritettavalukuvuodessa5 opintopistettätukikuukauttakohden. Opintopisteetlasketaankokolukuvuodenajalta,elisaadaksesikaiken opintotuensinunonsuoritettava vähintään45opintopistettävuodessa.Jossuoritatvähemmänopintoja, Kelapyytääsinultaselvitystäopintojenviivästymisestä.Josselvityksesi eikelpaa,Kelalakkauttaaopintotukesimaksamisentilapäisesti.Jos suoritatalle20opintopistettälukuvuodessataisinullaonliikaatyötuloja,Kelaperiitukeatakaisin.

Tukikuukausienmääräonrajattu 48:aan,jotkajaetaanalemmanja ylemmänkorkeakoulututkinnonkesken.Tarvittaessavoitanoalisäkuukausiahyvinperustein.Jossuoritat opintojamyöskesällä,voithakea opintotukeakesäkuukausillekin.Nämäkuukaudetvähennetäntukikuukausistasi.

Opintorahaonsuuruudeltaannoin 250euroa,minkälisäksivoitnostaa valtiontakaamaaopintolainaanoin 650euroakuukaudessa.Lainasopimustehdäänomanpankinkanssa. Jossuoritatalemmanjaylemmän korkeakoulututkinnonmääräajassa (jokaon6vuotta),Kelahyvittää opintolainasi2500euroaylittävästä osuudesta40%.
Opintotuenlisäksioletoikeutettu yleiseenasumistukeen,jotahaetaan erillisellähakemuksella.Lisätietoaja ohjeitakaikistaKelantuistaopiskelijallelöytyyosoitteestakela.fi/ opiskelijat:

Opiskelijantoimeentuloahelpottavat lukuisatopiskelija-alennukset,joita saaesimerkiksiopiskelijaravintoloista,monistakaupoistajajoukkoliikenteestäopiskelijakorttianäyttämällä.HSL(Helsinginseudun liikenne)antaaHSL-alueellavakituisestiasuvilleopiskelijoille40% alennustakausilipuista.Alennuksen saakuitenkinvainHSL-sovelluksella.Lisääopiskelija-alennuksia löytyyopiskelijakortittarjoavan Frank-palvelunverkkosivuilta:

Vaikkayliopisto-opintojensuunnitteluvoijoskustuntuavaivalloiselta, kannattaaomiaopintojasuunnitella japohtiahetiensimmäisestäkurssistalähtien!Pidäkorvatjasilmätauki, ihmettele,tutkijamuista,että yliopisto-opinnotovatmahdollisuuksiatäynnä.Sinäpäätät,tartutko niihin!

kanditutkielma,kandiseminaari, harjoittelusekämuutmysteerit
Kieliopinnotjatilastotiede
Kanditutkintoonkuuluupakollisena toinenkotimainenkielisekäyksi vieraskieli.Vieraaksikieleksi kannattaavalitaenglanti,mikäli mieliiHY:nkansainväliseen maisteriohjelmaantaihaluaasuorittaamaisterintutkintonsakokonaan englanniksi.Suomen-tairuotsinkieliseenmaisteriohjelmaaneiole englanninkielenvaatimusta,eli tällöinvieraskielivoihyvinolla myösmikätahansamuuyliopiston tarjoamakieli.Kieliopinnotvoi hyväksilukeatoisestakoulutusohjelmasta,mikälioletvaihtanutalaa.
Kieliopinnotvoitehdämyöstenttimällä,mikälihyvätkielitaidotovatjo olemassa.
Tutkinnossatuleesuorittaatilastotieteenopintoja,joitavoivalita muutamistavaihtoehdoista.Kursseillaperehdytääntaulukointiohjelmien jaohjelmointiympäristöjenkäyttöön, sekätilastollistenlaskentamenetelmienteoriaan.
Bio-jaympäristötieteellisessätiedekunnassakandiopintoihinkuuluu yksipakollinenharjoittelu,jokaon harjoittelunkestostariippuen5tai10 opintopistettä.Minimikestoharjoittelulleonyksikuukausikokopäiväisenä.Harjoittelunvoisuorittaayliopistontaimuuninstituution tutkimusryhmässä,valtionlaitoksessa,alanyrityksessätaikoulutusohjelmanlaboratorioassistenttina. Harjoittelukannattaasuorittaa palkallisena,jaHelsinginyliopiston ulkopuolellasuoritettavaanharjoitteluunvoihakeaharjoittelutukea,joka kattaaosanpalkasta.Mikälisuoritat harjoittelunkoulutusohjelmanlabrakurssinavustajana,etsaaharjoittelujaksostasipalkkaa.Useinmyös yliopistontutkimusryhmilläeiole valmiuksiaottaapalkallistaharjoittelijaa,muttavarsinkinpitkääpalkatontaharjoitteluakannattaavälttää. Harjoitteluonarvokastatyökokemusta,jaavaauseinovetseuraavaan työpaikkaan.Harjoittelupaikastavoi myösmuodostuapidempikestoinen työsuhdeopintojenoheen.

Kanditutkielma
Kandidaatintutkielmaonbio-ja ympäristötieteellisessätiedekunnassa20-sivuinenkirjallisuuskatsaus. Tutkielmasuoritetaanopintojen loppuvaiheessa,jollointyökalut omantietämyksensäsoveltamiseen ovatolemassa.Työarvioidaan asteikolla1-5jasiitäsaa6 opintopistettä.Opiskelijasaavalita tutkielmanaiheensaitse,mutta aiheentuleeluonnollisestiliittyäalan opintoihin.Lähteenätuleekäyttää alanvertaisarvioitujajulkaisuja,joita ovatesimerkiksitutkimusraportitja katsausartikkelit.Tutkielmankirjoittaminenonuseinmuutamankuukaudenaikanaeteneväprosessi, muttatyötunteihinkatsoensenvoi tehdäjopaviikoissa.Tutkielmaanon hyväpanostaa,sillätutkielman aihepiiristävoityöllistyäjo maisteriopintojenalussatutkimusryhmään.Myösmaisterinprogradututkielmanvoikirjoittaasamasta aihepiiristä,jolloinhyväennakkotietämysaiheestaonisoetu.Tutkielmanaihevalintaeikuitenkaan tarkoita,ettäsiihenpitäisikeskittyä myöskandiopintojenjälkeen.Voit valitaaiheesisinuakiinnostavasta kohteestataipyytääaihettasuoraan opettajalta.Jostyöskentelettutkimusryhmässäavustajana,kandisi aihepiirivoiliittyätyöhösija parhaimmillaanvoitjopasaada kandinkirjoittamisestapalkkaa. Kandiseminaari
Kandiseminaarielikandisemmaon useistaluennoistakoostuvakokonaisuus,jonkatarkoitusonperehdyttääopiskelijakandidaatintutkielman
tekemiseen.Kandisemmanyhteydessäsuoritetaanmyöspuheviestinnän opintojakso,jossaopiskelijapitää esitelmänkandityönsäaihepiiristä. Tässävaiheessakanditutkielmasaa ollavieläpahastikeskentaijopa aloittamatta.Kandiseminaarissaesiteltyaiheeisidotekemäänkandia kyseisestätutkimuskohteesta.

Kandiohjaaja
Kandidaatintutkielmantekemistä vartentarvitsetkandiohjaajan,jonka kanssasuunnitteletkanditutkielmasi tekoa.Kandiohjaajamyösarvioi kandityön.Kandiohjaajankanssa sovitaanmuutamapalaveri,jossa ohjaajaantaakorjauksiatekstiisi. Ohjauksenavullakandinkirjoittamisenaikataulupysyyyllä.Kandiohjaajapitäähankkiaitse,japarhaitenseonnistuusähköpostitsekysymällä.Kandiohjaajavoiollajoku koulutusohjelmanopettajistataimuu yliopistollatyöskentelevähenkilö, esimerkiksijostyöskentelet tutkimusavustajanatutkimusryhmässä,tutkimusryhmäntutkijavoitoimia kandiohjaajanasi.
Kypsyysnäyte
Kypsyysnäytteentarkoitusontodistaa,ettäkandinonkirjoittanutopiskelijaitse,eikäjokumuu.Kypsyysnäyteonkandiohjaajanlaatimatentti kandinaihepiiristä.Tenttionläpäistävä,jottatutkinnonsaasuoritettua. Kypsyysnäytteestäeisaaopintopisteitä.Ainakinpandemia-aikana kypsyysnäytteeksionhyväksytty myöstutkielmantiivistelmä.
Suurinosaopinnoistaonperinteisiä luentokursseja.Luennoillaeiyleensä oleläsnäolopakkoajaluentojen materiaalittulevatuseinMoodleen nähtäville.Luentokurssinläpäisyyn riittääluentosarjantentin(eli kokeen)suorittaminenhyväksytysti. Tentitarvostellaanasteikolla0–5, jotenjostentistänapsahtaanelonen, voititkunsijastatuulettaavillisti. Pieniosakursseistaarvostellaan asteikollahylätty–hyväksytty,jolloin asiayleensämainitaankurssin kuvauksessa.
Laboratorio-,kenttä-jaharjoitustyökursseillataaspääsetitsekokeilemaankirjoistatuttujaasioita.Näillä kursseillaonluonnollisestiläsnäolopakkojalisäksikursseihinkuuluu erilaistenselostustenjaraporttien kirjoittamista.Kenttäkursseillalähdetäänmaastoon,joskususeammaksi viikoksikinopiskelemaanjaihmettelemään.
Opintoihinsaattaamyössisältyä kirjatenttejä.Kirjatenttiävarten opiskellaanjokinetukäteensovittu oppikirjanaihealuejasuoritetaan siihenliittyvätentti.Kirjatentin suorittaminensovitaanainakirjan aihealueenmukaanmääräytyvän vastuuopettajankanssa.Tentti suoritetaantyypillisestiyleisen tenttitilaisuudenyhteydessätai joustavamminsähköisesti.




Maisteriohjelmaansiirtyminen
Bio-jaympäristötieteellisessätiedekunnassaonvalittavissauseitaeri maisteriohjelmia.Opiskelupaikan varmistettuasisaitmyösopintooikeudenylempäänkorkeakoulututkintoon,muttaetpääsealoittamaan haluamassasimaisteriohjelmassa automaattisesti.Maisteriohjelmiin tuleeilmoittautuailmoittautumislomakkeellakandiopintojenloppuvaiheessa.Ilmoittautumistenperusteella maisteriohjelmienjohtoryhmättekevätopiskelijavalinnatjatarjoavat paikkaamaisteriohjelmiin.Opiskelijoitapriorisoidaanensisijaisesti opintomenestyksenperusteella, mikäliopiskelijoitailmoittautuu maisteriohjelmaankiintiötäsuurempimäärä.Tarjottuopinto-oikeus maisteriohjelmaanonvoimassailmoittautumisajankohdastariippuen6 tai12kuukautta,mikätarkoittaa,että tämänajanpuitteissatuleevalmistua kandiksijaaloittaamaisteriopinnot. Maisteriohjelmailmoittautuminenon aukikaksikertaavuodessa,keväisin jasyksyisin.Voitmyöshakea muidentiedekuntienjayliopistojen maisteriohjelmiinyhteishaussa,jos täytäthakuvaatimukset.
oppikirjatovatuseimmitenluettavissatietokoneellataitabletilla yliopistonkirjastonnettisivujen kautta. Yliopistossaopiskeluvaatii itseohjautuvuutta
Yliopistossaopiskelutyyliontoisen asteenoppilaitokseenverrattuna vapaampi,mikäasettaamyös opiskelijallevastuutaomasta etenemisestään.Niinsanottuakateeminenvapaustarkoittaa,että esimerkiksiluennoilleeioleyleensä pakkomennäjaopintojasaa suorittaaomallatyylillään.Opettajat eivätseuraayksittäisenopiskelijan etenemistä,vaanopiskelijanonitse pysyttäväperilläomastaopiskelutahdistaan.Omanaikataulunylläpitämistäauttaaesimerkiksikalenteritai muumuistio.Kursseillaonkuitenkin useinajastettujapakollisiatehtäviä, jotkarytmittävätopintoja.Kursseilla lisätehtävätovatkorostuneeterityisestipandemia-aikaan,silläetäopiskelussatenttienjärjestäminenmonimutkaistuujalähiopetuksenpuuttuessatehtävätauttavatopiskelijaa pysymäänaikataulussa.
Elektronisetoppimisympäristötaukeavatkotisohvaltakäsin
Joennenpandemia-aikaayliopistokursseillaolisiirryttypitkältielektronisiinoppimisympäristöihin.Helsinginyliopistossakeskiössäon Moodle,jokatarjoaajokaiselle kurssilleomansivustonsa.Usein Moodleenpäätyvätmyöstallenteet kaikistaluennoista,jasiellävoi suorittaakurssitehtäviä.Myös
Yliopistossatutkijanluonnettaanpääseeharjoittamaanjoperuskursseilla, silläaivankaikkeaeioleselitetty auki,vaanopiskelijanonomaaloitteisestietsittävätietoajalöydettäväratkaisuja.Itsenäinentiedonhakuonkeskiössäyliopistoopinnoissa,minkäviimeistäänhuomaaloppututkielmaakirjoittaessa. Jossiisnäetoudonkäsitteen luentokalvolla,kysyrohkeastiopettajalta,etsivastausluotettavista lähteistätailuekurssinoppikirjaa.


IT-jutut pähkinänkuoressa
HelpDeskin kooste uudelle opiskelijalle
Melkeinpä kaikki yliopiston sivustot toimivat yliopistolaisen käyttäjätunnuksella tai sähköpostilla. Jos et ole vielä aktivoinut tunnuksiasi, se kannattaa tehdä mahdollisimman pian. Koosteessa on paljon hyviä ohjeita mm. tulostamiseen ja kampuksen langattomaan verkkoon yhdistämiseen.
Opintoni-sivut
Täältä löytyy tärkeimmät asiat ja linkit, kuten opiskelijan ohjeet ja lukujärjestys.
Sisu
Opintotietojärjestelmä. Opintojen suunnittelu, kursseille ilmoittautuminen, kurssien tiedot, suoritukset ja arvosanat.
Moodle
Kurssien työpöytä, eli luentomatskut, tehtävien palautus ja tentit.
Helka-kirjasto
Kampuskirjaston sivut. Kirjojen varaaminen ja lainojen uusiminen, e-kirjoja, tieteellisten julkaisujen tietokantoja.
MOT-sanakirja
Erittäin pätevä sanakirja.
IT-HelpDesk
Apua ja neuvoja IT-pulmiin.
Pakollisia juttuja?!
Mitä häh? Tavoitteena on varmistaa, että jokaisella opiskelijalla on riittävät taidot digitaalisten oppimisympäristöjen ja työkalujen käyttöön sekä hyvä käsitys tietoturvasta.
Opiskelijan digitaidot
Kurssin oppimateriaali
Opiskelijan digitaidot on kaikille alempaa korkeakoulututkintoa suorittaville perustutkinto-opiskelijoille pakollinen opintojakso. Kurssi suoritetaan omalla ajalla itseopiskelulla ja verkkotentillä.
Tietoturvatesti
Sekä opiskelijat että henkilökunta suorittavat kerran vuodessa tietoturvatestin. Testin suorittamisesta tulee sähköpostiin muistutus. Testi tulee läpäistä hyväksytysti määräaikaan mennessä, muuten tunnus lukitaan.
Microsoft 365
Yliopistolla on käytössä Microsoft 365 -palvelut, johon kuuluu mm. sähköposti, pilvitallennus ja etäyhteys. Opiskelijat voivat ladata Microsoftin sovellukset omalle koneellensa. Sähköpostia voi lukea selaimella ja tietokoneen tai puhelimen Outlook-sovelluksella.
Officen asennus kotikoneelle
Outlook iOS-laitteille (ohje)
Outlook Android-laitteille (ohje)


Opintojesiaikanasaattietoa,tukeajaapua terveyteenliittyvissäkysymyksissäYlioppilaidenterveydenhoitosäätiöYTHS:stä. YTHStarjoaayleisterveyden,mielenterveydenjasuunterveydenpalveluitaperustutkintoasuorittavillekorkeakouluopiskelijoille lukuunottamattavaihto-opiskelijoitaja avoimenyliopistonopiskelijoita.
Yleisterveydenpalveluihinkuuluuterveyden-jasairaanhoitajiensekäyleislääkärien vastaanottojenlisäksimm.fysioterapiaaja seksitautienetätestausta.Suunterveyden palveluitaovathammashygienistinvastaanottosekähammas-jaerikoishammaslääkäripalvelut.Mielenterveydenongelmissasaat apuaYTHS:nsairaanhoitajiltajapsykologeilta.Mielenterveyspalveluilleonkuitenkin paljonkysyntää,jasaatatjoutuaodottamaan pitkäänkinpsykologillepääsyä.Sairaanhoitajiltasaatkuitenkinapuanopeammin.
KaikkiYTHS:npalvelutovatilmaisia,mutta käyttämättömistäjaperuuttamattomista ajoistaperitäänmaksu.Sinunonkuitenkin maksettavajokalukukausipakollinenKelan terveydenhoitomaksuhuolimattasiitä käytätköpalveluitavaiet.Maksusuoritetaan oma-aloitteisesti,löydätlisätietoaja maksuohjeetKelanverkkosivuilta.
Yleis-jamielenterveydenpalveluttoimivat HelsingissäMalmintoimipisteelläja suunterveydenpalvelutTöölöntoimipisteellä.Hoidontarpeenarviotjaajanvaraukset tehdääntakaisinsoittopalvelunkautta.
OhjeetlöytyvätYTHS:nverkkosivuilta osoitteestayths.fi:
Yhdenvertaisuuttaja hyväämeininkiä!


Tänäkinvuonnameilläaloittaamontauutta fuksia,joistakukintuleehiemaneri lähtökohdista.Opiskelijammemuodostavat hyvinheterogeenisenjoukon,minkätakia yhdenvertaisuusvastaavatpitäväthuolen siitä,ettäjokaisellaonsamatmahdollisuudet osallistuaainejärjestöjentapahtumiinomana itsenääntulemattasyrjityiksi.Syrjintään lukeutuumuunmuassakaikkikieleen, uskontoontaivakaumukseen,seksuaaliseen suuntautumiseen,sukupuoleen,etniseen ryhmääntaikansalaisuuteen,terveydelliseen tilaantaimihintahansamuuhunominaisuuteenliittyväsyrjivätaihalveksivatoiminta. Ainejärjestöjemmeyhteisettilat,kuten kerhohuoneet,ovatniinikäänsyrjintävapaitaalueita,joissanoudatetaanturvallisentilan periaatteita.
Meilleontärkeää,ettäjokainentuntee olonsaarvokkaaksijahyväksytyksiomassa opiskelijayhteisössään.Yhdenvertaisuusvastaavatvaalivathyväämeininkiäjapuuttuvat tarvittaessamyöskiusaamistilanteisiinja muihinongelmiin.Heihinvoiolla yhteydessäesimerkiksisähköpostinkautta taitulemallanykäisemäänketävainheistä suoraanhihasta,josjokinasiaaskarruttaa mieltä.Molemmillajärjestöilläonmyös käytössähäirintälomake,jonkakauttaon mahdollistajättääanonyymiäviestiäminkä vainyhdenvertaisuuttakoskevanasian tiimoilta.Yhdenvertaisuusvastaavatkäsittelevätkaikkitilanteetluottamuksellisesti, jotenheillejutteluaeitarvitsejännittää.He ovattäälläteitävarten!
Symbioosin yhdenvertaisuusvastaavat
Camilla Kontto – camilla.kontto@helsinki.fi
Laura Muukkonen – laura.muukkonen@helsinki.fi
Symbioosinyhdenvertaisuusvastaavat: MiriamRonkainen -miriam.ronkainen(at)helsinki.fi HenriikkaHovi -henriikka.hovi(at)helsinki.fi
LauraMuukkonen -laura.muukkonen(at)helsinki.fi
Helixin yhdenvertaisuusvastaavat
Sanna Tervo – sanna.tervo@helsinki.fi
Ella Kärkkäinen – ella.karkkainen@helsinki.fi
Helixinyhdenvertaisuusvastaavat: Anna-KaisaErkanaho -anna-kaisa.erkanaho(at)helsinki.fi IidaJuntunen -iida.j.juntunen(at)helsinki.fi
Jani-Matti Pärkkä – jani-matti.parkka@helsinki.fi
SannaTervo -sanna.tervo(at)helsinki.fi
Tuuli Kirkinen – tuuli.kirkinen@helsinki.fi
RebekkaKukowski -rebekka.kukowski(at)helsinki.fi
Biologiaa kutsutaan elämän tieteeksi, ja se kattaakin kaiken elollisen meren hämärien syvyyksien ja avaran taivaan väliltä. Tutkittavien asioiden koko vaihtelee mikroskooppisista eliöistä aina maailmanlaajuisiin ekosysteemeihin asti. Biologit matkustavat ajassa vuosimiljoonia taaksepäin evoluution kysymysten äärellä, mutta myös tulevaisuuteen ratkoessaan esimerkiksi ilmastonmuutoksen vaikutuksia.
Biologian kandiohjelmassa on valittavana viisi eri tieteenalaa: ekologia ja evoluutiobiologia, kasvitiede, perinnöllisyystiede, mikrobiologia sekä fysiologia ja neurotiede. Ensimmäinen vuosi koostuu kaikille yhteisistä perusopinnoista, ja toisesta vuodesta lähtien perehdytään omaan tieteenalaan. Kandidaatiksi valmistumisen jälkeen syventyminen jatkuu tieteenalojen omissa maisteriohjelmissa. Myös aineenopettajan linjalla valitaan oma tieteenala, mutta tutkintoon kuuluu myös toinen opetettava aine sekä pedagogisia opintoja.
Hei Sinä, joka haluat osallistua tulevien viherpeukaloiden istutustyöhön, rakastat ääntäsi tai muuten vain tykkäät tarinoida, olet cool: pukeudut lökäpöksyihin ja puhut slangia, kestät pitkät loma-ajat sekoamatta, et tunnista itseäsi edellisistä, mutta polte kasvatustyöhön kytee sisälläsi!
Biologian aineenopettajan taival käy hakuhaastattelun, pääaineopintojen ja ikimuistoisten kenttäkurssien kautta toisen opetettavan aineen opintoihin ja edelleen opettajankoulutuslaitoksen (käyttäytymistieteellinen tiedekunta) suuntaan. Toisen opetettavan aineen opinnot sijoittuvat kandivaiheeseen ja pedagogiset opinnot ovat vasta maisterivaiheessa. Opintoihin sisältyy siis paitsi luonnontieteitä myös ihmistieteiden näkökulmia. Älkää kuitenkaan peljätkö: humanismi on huumaavaa!
Aineenopettajan suuntautumisvaihto tarjoaa monipuolisen ja yleissivistävän keitoksen, jonka ainekset pääset itse valitsemaan. Perinteisesti bilsan maikka opettaa bilsan ohella mantsaa. Kukaan ei kuitenkaan estä sinua lukemasta 60 opintopisteen sivuainekokonaisuutta kemiasta, terveystiedosta tai vaikkapa köksästä!

Aineenopettajan ABC
Häh?! Aineenopettajan suuntautumisvaihtoehto: ihmisläheisen ja ympäristötietoisen tulevaisuuden puolesta.
Hmm...?! Päätöstä ei tarvitse stressata opintojen ensimetreillä. Hakeminen ei velvoita mihinkään, joten rohkeasti mukaan kevään hakuhaastatteluihin!
Huh?! Opettajien työllistyminen ei nykymaailmassa ole itsestäänselvyys. Suojatyöpaikan perässä ei siis kannata lähteä juoksemaan...
Hih?! Opettajan pedagogiset opinnot voi suorittaa kahdessa osassa tai yhteen pötköön. Vuosi opettajankoulutuslaitoksella haastaa ajattelemaan opettajuuden koukeroita oikein kunnolla.
Pysähdyhän lopuksi muistelemaan omia kouluaikojasi. Minkälainen on hyvä opettaja? Voitko kuvitella itsesi kasvattajana: nuoren esikuvana ja tukipilarina?
Mikä on johtanut tähän kaikkeen elämän monimuotoisuuteen? Miten ympäristö vaikuttaa eliöön ja päinvastoin? Mihin suuntaan luonnonvalinta ajaa kehitystä? Millaisia ovat eliöiden sukulaisuussuhteet ja evoluutiohistoria?
Ekologia ja evoluutiobiologia tarjoavat laajimman näkökulman biologiaan, jossa tarkastellaan elämän ihmettä aina genomitasolta yhteisötasolle. Luonnonvalinnan ja sattuman vaikutuksen ymmärtäminen on avain tietoon siitä, miksi luonnossa on sekä monimuotoisuutta että toistuvuutta. Ekoevo tarjoaa tähän vastauksia, sillä mikään biologiassa ei käy järkeen muuten kuin evoluution valossa.
Opintojen aikana ymmärrät, miten ympäristö, sopeutuminen ja evoluutio vaikuttavat eliöihin. Ekologi on asiantuntija, joka kykenee ymmärtämään biologian laajan ja monimutkaisen verkoston. Opit, miten tätä vyyhtiä ylipäätään pystyy tutkimaan ja selittämään. Ehkä tärkeimpänä, ymmärrät miten tätä kaikkea voisi suojella.
Opintoihin kuuluu työskentelyä sekä maastossa että laboratoriossa. Simulaatiot eri ohjelmilla antavat tarvittavia työkaluja tutkimukseen. Kenttäkursseilla perehdyt luontoon ja sen tutkimukseen Lammin lisäksi Kilpisjärvellä tai Keniassa, tietysti mitä parhaimmassa ja asiantuntevimmassa seurassa!

Kasvitiede
Mitä kasvit oikein tekevät? Miten kasvit aistivat ympäristöään ja reagoivat erilaisiin olosuhteisiin? Miten on mahdollista, että kasvit pysyvät koko elämänsä samalla paikalla ja saavat silti kaiken tarvittavan selviytymiseen?
Kasvitieteen opinnoissa tutustut tähän hiljaiseen ja hieman mystiseen eliöryhmään. Kasvitieteen ala on laaja: tutkittavaa riittää solu- ja molekyylitasolta aina yhteisöjen ekologiaan ja lajien evoluutiohistoriaan asti. Maapallon biomassasta noin 90% koostuu kasveista, joten ne ovat hyvinkin merkittävä osa luontoa. Myös viljely ja puutarhan hoito ovat ihmisen kannalta tärkeitä.

Opinnoissa on tarjolla luento- ja laboratoriokursseja, retkeilyä sekä itsenäisesti suoritettavia kursseja. Labrassa perehdytään kasvien fysiologiaan ja anatomiaan mikroskoopin ja koeputkien äärellä. Parin päivän retkiä järjestetään Lammille ja Ahvenanmaalle. Kenttäkurssit Kilpisjärvellä ja Keniassa tarjoavat erikoisempia kasveja ja upeita maisemia. Itsenäisesti voi suorittaa lajituntemusta, kerätä oman kasvion tai tutustua kasvien talveen.
Kasvitiede tarjoaa mielenkiintoisia juttuja sekä ekologeille että labrassa viihtyville. Loppujen lopuksi sekä valkotakki että kumpparit saattavat kuulua vaatekaappiisi: kasvifysiologin voi löytää metsästä sahailemasta puunäytteitä yhtä hyvin kuin ekologin labran uumenista tekemässä PCR-ajoa.

Miten perinnöllisyys ilmenee yksilössä? Miten suhteellisen yksinkertainen molekyyli voi olla niin merkittävä? Miten tätä kaikkea toimintaa säädellään? Entä mitä kaikkea kokonaisesta genomista voidaan selvittää?
Perinnöllisyystiedettä eli genetiikkaa voi opiskella sekä biologian että molekyylibiotieteiden koulutusohjelmassa. Klassisen määritelmän mukaan genetiikka tutkii eliön ominaisuuksien perinnöllisyyden säännönmukaisuutta. Sen jälkeen kun 1950-luvulla osoitettiin DNA:n sisältävän perinnöllistä informaatiota, tutkimus on keskittynyt tämän kiehtovan molekyylin toimintaan.
Perinnöllisyystiede on tämän päivän biologian sydämessä. Geenitekniset menetelmät ovat arkipäivää sekä valkotakeilla että ekologeilla. Pipetin lisäksi olennainen työkalu on tietokone, kun bioinformatiikassa yhdistyvät molekyylibiologia ja tietojenkäsittely. Tietokannat pursuavat ihmisen ja useiden eliöiden genomeja, ja lisää tulee jatkuvasti. Tutkittavan sekvenssin vertailu tietokantaan antaa tietoa esimerkiksi sen tuottamasta proteiinista. Useamman genomin vertailu keskenään taas valaisee evoluutiohistoriaa. Genomit ovat myös valtavia tiedostoja, joiden käsittelyyn tarvitaan erityisiä ohjelmia.
Perinnöllisyystieteen opetus ja tutkimus painottuvat suurin osin molekyylitasolle. Luentokursseillu opittuja asioita pääsee käytännön kautta oivaltamaan lukuisilla labrakursseilla. Biologian kannalta huomionarvoista on myös ekoevon kvantitatiivisen ja populaatiogenetiikan opetus ja tutkimus.
Mikrobiologia
Miten mikrobit menestyvät maailman kolkassa? Miksi tärkeitä, kun taas toiset aiheuttavat näitä mikroskooppisen pieniä tutkitaan?
Mikrobiologiassa pääset virusten ja muiden pienen seen maailmaan. Mikrobeilla kitys niin ihmisille, eläimille ton mikrobit vaikuttavat aivoihin mikrobi on myös taudinaiheuttaja. sienten ja bakteerien kanssa den ja typen saamiselle, mutta tuhota sadon.
Välillä mikrobiologi ulos kentälle. Rottia jahdataan tukseen, influenssaa seurataan linnuista, punkkeja haavitaan bakteereita kaivellaan Lammilla. dynnetään esimerkiksi biotekniikassa ollisuudessa, ja uusia keksintöjä voi aina kehitellä!
Viikissä virustutkimuksella
Labrakursseilla pääset perehtymään nistamisen menetelmiin sekä elektronimikroskoopissa. sesti myös esim. molekyylibiologiaa sitten voit opiskella kaiken

Mikrobiologia
menestyvät melkeinpä missä tahansa Miksi jotkin mikrobit ovat elinaiheuttavat sairauksia? Miten pieniä ja näkymättömiä eliöitä
pääset tutustumaan bakteerien, pienen pienten eliöiden ihmeelliMikrobeilla on ollut aina tärkeä mereläimille kuin kasveillekin. Suolisaivoihin ja terveyteen, ja moni taudinaiheuttaja. Kasvien symbioosi kanssa on olennaista kasvin vemutta toisaalta perunarutto voi
astuu labran seinien sisältä jahdataan kaduilla loisten kartoiseurataan ottamalla virusnäytteitä haavitaan tutkittaviksi tai maaperäLammilla. Mikrobeja myös hyöbiotekniikassa ja elintarviketekeksintöjä ja käyttötarkoituksia
virustutkimuksella on pitkät perinteet. perehtymään bakteerien tunsekä tarkastelemaan viruksia Opintoihin kuuluu olennaimolekyylibiologiaa ja biokemiaa, tai kaiken mahdollisen vaikka sienistä.


Millaisia sopeumia eläimillä on vedessä elämiseen tai ilmassa lentämiseen? Mikä säätelee reaktioita ja käyttäytymistä? Kuinka yksittäisestä solusta kehittyy täysikokoinen aikuinen?
Fysiologia ja neurotiede tutkii elimistön toimintaa molekyylien, solujen, kudosten, elinten ja yksilöiden tasolla. Muuntogeeniset eläimet ovat tärkeitä malleja, joilla saadaan korvaamatonta tietoa geenien tai ympäristön vaikutuksista yksilössä. Neurotieteessä tutkimuskohteena on eläinten käyttäytymistä säätelevä hermojärjestelmä. Tutkimuskohteena voi olla yksittäinen hermosolun ionikanavaproteiini tai kokonaisen hermoston toiminta.
Fysiologian opinnoissa perehdyt eläimen toimintaan yksittäisen solun tasolta laajempiin kokonaisuuksiin, kuten liikkumiseen. Aistien toiminta, "omiikat" eli biomolekyylien kokonaisuuksien tutkiminen ja yksilönkehitys ovat keskeisiä opintokokonaisuuksia. Neurotiede on hyvin poikkitieteellinen tieteenala, ja kiinnostus esimerkiksi fysiikkaan tai toisaalta psykologiaan on usein hyödyksi.
Helsingin yliopistossa on korkeatasoista fysiologian ja neurotieteen tutkimusta. Fysiologiaa ja neurotiedettä opiskelemaan aikovan kannattaa varautua siihen, että koe-eläimiä käytetään opetuksessa ja tutkimuksessa.
Seuraavaksi esitellään kursseja, joihin tulet ensimmäisenä opiskeluvuotenasi törmäämään. Näillä kursseilla saat maistiaisen jokaisesta biologian tieteenalasta ja voit samalla pohtia omien opintojesi tulevaa suuntaa.

Biologian asiantuntija I
Tämä kurssi integroituu orientaatioviikon infotilaisuuksiin ja jatkuu kevääseen asti. Kurssilla eri asiantuntijat ja vanhemmat opiskelijat kertovat tärkeää tietoa biologian kandiohjelman rakenteesta, tieteenaloista ja muista opiskeluun liittyvistä jutuista.
Kurssi johdattaa opiskelijat yliopiston maailmaan kuten tieteelliseen kirjoittamiseen ja viittaamiseen. Jokainen opiskelija myös kartoittaa oman opiskelutyylinsä (HowULearn -kysely) ja saa vinkkejä opiskelutaitojen hiomiseen.
Kemian perusteet
Opinnot alkavat kemian laitoksen järjestämällä kemian perusteiden luentosarjalla. Lukion pitkän kemian käyneille luennot ovat lähinnä kertausta, vähemmän kemiaa lukeneille kurssilla sen sijaan riittää tekemistä. Kurssin luentomonisteella tai lukion kemian kirjoilla pärjää pitkälle. Kemian perustiedot on hyvä hallita, sillä kemia selittää monia keskeisiä biologisia ilmiöitä. Seuraavilla luentokursseilla kemia tuleekin jälleen vastaan, joten kannattaa tulla paikalle edes laskuharjoituksiin!
Eliökunnan evoluutio
Luennoilla perehdytään biologian ytimeen eli evoluutioon. Kurssin tavoitteena on ymmärtää luonnonvalinnan ja evoluution keskeisimmät ilmiöt ja toimintatavat, jolloin opiskelija osaa pohtia kriittisesti evoluutioteoriaa koskevia käsityksiä. Luennoilla pikakelataan miljoonien vuosien läpi ja perehdytään eliökunnan kehityksen tärkeimpiin tapahtumiin. Systematiikan luennoilla kerrotaan perustiedot eliöiden luokittelusta ja fylogeneettisen sukupuun tulkinnasta.
Eläin- ja kasvikunnan rakenne
Kurssi tarjoaa kattavan kokonaiskuvan eläinja kasvikunnan monimuotoisuudesta ja evolutiivisesta taustasta. Kurssi on jaettu eläin- ja kasviosioon, joissa opit kummallekin ryhmälle tyypillisimmät sopeumat elinympäristöön.
Luennoilla käydään läpi runsaasti termejä liittyen eliöiden luokitteluun ja tuntomerkkeihin, mikä on olennaista lajituntemuksen kannalta. Eläinosiossa käsitellään ja preparoidaan oikeita näytteitä. Tässä kurssilla on avustamassa kädestä pitäen assistentit eli assarit. Kurssilla käydään läpi pääryhmät järjestyksessä mikroskooppisen pienistä loisista nilviäisiin ja selkärankaisiin saakka.
Kasviosiossa käydään läpi kasvien pääryhmät ja niiden evolutiiviset erot. Kurssilla käydään Viikin arboretumissa keräilemässä kasvinäytteitä, joita tutkitaan tarkemmin luentosalissa mikroskoopin ääressä. Pääset myös vierailemaan Kaisaniemen kasvitieteellisessä puutarhassa ja kasvimuseolla.
Genetiikan perusteet
Tällä luentokurssilla luot pohjan paitsi geneettiselle ymmärrykselle, myös muille biologian opinnoille. Luennoilla kuulet perinnöllisyyden lainalaisuuksista, geenien rakenteesta ja toiminnasta sekä geneettisestä muuntelusta ja sen evolutiivisesta merkityksestä.
Luennoilla käydään läpi nukleiinihappojen, geenin, kromosomin ja genomin rakenteet. Lisäksi käsitellään ominaisuuksien periytymisen lainalaisuuksia, geenien ilmentymisen säätelyä, epigenetiikkaa, kehitysgenetiikkaa, bioinformatiikkaa ja geneettisen muuntelun merkitystä sekä yksilö- että populaatiotasolla.

Mikrobien monimuotoisuus, rakenne ja toiminta
Kurssilla tutustutaan mikrobien kiehtovaan maailmaan. Kurssilla käydään läpi keskeisimmät mikrobien ryhmät ja miten nämä mikroskooppisen pienet organismit toimivat. Mikrobien rakenne selittää, miten mikrobien ominaisuudet tekevät tästä porukasta juuri omanlaisensa. Luennoilla pohditaan mikrobien ekologista ja kliinistä merkitystä ja käydään läpi pöpöjen infektion mekanismeja. Lisäksi tutustutaan mikrobien tutkimusmenetelmiin ja bioteknologiseen hyötykäyttöön.
Ekologian perusteet
Ekologian perusteiden luennoilla tutustutaan ekologiaan yksilön, populaatioiden, eliöyhteisöjen ja ekosysteemin näkökulmasta. Näiden tasojen lisäksi ekologiaa pohditaan eri eliöryhmien ja biomien kannalta. Kurssilla opitaan käsittämään ekologisten prosessien merkitys ja miten tätä tietoa hyödynnetään luonnonsuojelussa. Kaavoja ja erityisesti ”käppyröitä” on runsaasti, mutta alun kauhistuksen jälkeen ne usein osoittautuvat varsin simppeleiksi. Luentosarja antaa mukavan yleiskuvan ekologian laajasta maailmasta, mistä on hyvä jatkaa perehtymistä seuraavilla kursseilla.
Kasvi- ja eläinfysiologian perusteet
Kurssi on jaettu kasvi- ja eläinosioon, ja luennoilla käydään läpi niiden anatomiaa ja fysiologiaa. Kurssin tavoitteena on valaista, mitä eliöissä tapahtuu ulkokuoren sisällä ja miten vuorovaikutus ympäristön kanssa vaikuttaa kaikkeen. Kurssilla perehdytään eläinten ja kasvien elämään solujen, elinten ja rakenteen kautta. Luennoilla opitaan, miten näiden eliöryhmien monimutkaiset säätelyjärjestelmät toimivat ja miten eliöt vastaavat ympäristöön ja sen muutoksiin.
Molekyylibiotieteiden harjoitustyökurssi
Tämä on ensimmäinen laboratoriokurssi sanan perinteisessä merkityksessä. Kurssi on jaettu biokemian ja mikrobiologian osioihin.
Labroja edeltää luentojakso, jossa käydään läpi labrassa työskentelyn ja turvallisuuden perusteet. Labrassa opetellaan käsittelemään keskeisimpiä työkaluja ja laitteita, kuten pipettiä, spektrometriä ja sentrifuugia. Kurssilla myös opetellaan täyttämään laboratoriovihkoa, mikä on olennaisin työvaihe labrassa työskentelevälle.
Huom: tarvitset oman labratakin, jolle on käyttöä jatkossakin. Helix hoitaa fuksien labratakkimyyntiä, ja takkeja voi myös lainata ainejärjestöiltä.

Tieteellisen laskennan perustaidot ja jatkoharjoitukset
Kurssi johdattaa kädestä pitäen tietojenkäsittelyn eli taulukoiden, graafien ja koodauksen maailmaan R ohjelmointikielen avulla. Kurssilla tutustutaan myös tiedonsiirtoon supertietokoneen Unix-järjestelmän avulla, jota tarvitaan esimerkiksi valtavien sekvenssitiedostojen käsittelyssä. Koodinpätkien tuijottaminen saattaa kuulostaa kuivalta ja ehkä myös pelottavalta, mutta kurssilla ei tarvita minkäänlaisia esitietoja. Luentojen harjoituksissa pidetään huolta, että kaikki pysyvät kärryillä. R ohjelmointikieltä käyttävä RStudio on näppärä ohjelma, jolla dataa voi esittää ja käsitellä monipuolisesti. Sitä käytetäänkin paljon tutkimuksen teossa, ja todennäköisesti tulee uralla vastaan silloin tällöin.
Eliöiden monimuotoisuus
Jos joku on stereotyyppinen biologian kurssi, niin se on tämä. Kurssilla opetellaan tunnistamaan Suomen yleisimmät eläin- ja kasvilajit. Kurssilla käydään läpi eliöiden tunnistuksen osalta olennaisimmat tuntomerkit ja termit. Kurssin jälkeen myös ymmärtää, miksi asiantuntijalta kysyttäessä lajin määrityksestä vastauksena on ’se vain on itsensä näköinen’. Eläinosuudessa käydään läpi hyönteisiä, nilviäisiä ja selkärankaisia. Tiedossa on siis mielenkiintoisia hetkiä viinassa lilluvien ötököiden, frisbeetä muistuttavien myyrännahkojen ja siivettömien perhosten äärellä. Kasviosuudessa käydään läpi putkilokasveja, itiökasveja ja sieniä. Pinkassa voi selata kasvien kuvia ja testata lajien osaamista. Mahdollisuuden mukaan käydään myös maastossa, mikä on erittäin tehokas tapa oppia lajeja.
Ekologian kenttäkurssi –elinympäristöt ja lajisto
Ikimuistoiset kaksi viikkoa Lammin biologisella asemalla! Kevään luennoilla käydään läpi eri biotoopit ja eliöt, joita kesällä tullaan näkemään. Retkeilyä on luvassa niin metsässä kuin suollakin, tietysti kauniissa etelähämäläisessä maalaismaisemassa. Asemalla illat kuluvat mukavasti biologien rennossa seurassa ja järvellä saunoen ja uiden.
Kun lajituntemuksen kurssilla on juuri päntätty kaikki mahdolliset kukat ja linnut, nyt niitä pääsee näkemään tai kuulemaan ihka elävinä. Kurssilla opiskelijat tutustuvat jokaiseen kurssin eliöryhmään, ja perehtyvät lähemmin niistä yhteen ryhmissä.

Tutkimuksen teon perusteet
Kurssi koostuu koesuunnittelusta ja sen toteuttamisesta. Keväällä luennoidaan tutkimuksen tekemisestä ja suunnitellaan ryhmissä ihka oma tutkimus. Kurssi järjestetään Viikissä, mutta aineiston keruu voidaan tehdä esimerkiksi Lammilla.
Kesällä työskennellään ryhmän kanssa tutkimusaiheen parissa, joka liittyy vaikkapa kaupunkiekologiaan, lintuihin tai kasvien elämään. Kolmessa viikossa kerätään tutkimukseen tarvittava aineisto, analysoidaan se ja kirjoitetaan päätelmät ja yhteenveto loppuraporttiin.
Kurssilla opetellaan tieteellisen tutkimuksen suunnittelun ja raportin kirjoittamisen perusteet, mistä on suuresti hyötyä aivan jokaiselle biologille. Kurssille kannattaa siis osallistua, vaikka kumisaapastelu ei kuuluisi omaan urasuunnitelmaan. Kurssia pidetään yhtenä parhaana biologian koulutusohjelman kursseista.

Perusopinnot, 25 op

BIO-101 Eliökunnan evoluutio 5 op
BIO-102 Eläin- ja kasvikunnan rakenne 5 op
BIO-103 Eliöiden monimuotoisuus 5 op
BIO-104 Ekologian perusteet 5 op
MOLE-102 Genetiikan perusteet 5 op
Toimiva organismi, 28 op
BIO-201 Molekyylit ja solut 3 op
BIO-203 Ihmisen fysiologia 5 op
BIO-204 Ekologian kenttäkurssi - elinympäristöt ja lajisto 5 op
MOLE-212B Molekyylibiotieteiden harjoitustyökurssi (biokemia) 2 op
MOLE-212D Molekyylibiotieteiden harjoitustyökurssi (mikrobiologia) 3 op
MOLE-103 Mikrobien monimuotoisuus, rakenne ja toiminta 5 op
BIO-202A Kasvifysiologian perusteet 3 op
BIO-202B Eläinfysiologian perusteet 2 op
Menetelmätieteet, 25 op
KEK110 Kemian perusteet 5 op
BIO-205 Biotieteiden matematiikka ja fysiikka 5 op
MOLE-210 Tieteellisen laskennan perustaidot ja jatkoharjoitukset 5 op
MOLE-211 Bioinformatiikka 5 op
ME-004 Tilastotiede I: Tilastollisen ajattelun perusteet 2 op
ME-005 Tilastotiede II: Tilastollisten menetelmien perusteet 3 op
Tieteellinen viestintä, 9 op
BIO-211 Kandidaatintutkielma 6 op
VIIKB-004 Kypsyysnäyte 0 op
BIO-222 Kandidaattiseminaari: ekologia ja evoluutiobiologia, perinnöllisyystiede, kasvitiede, mikrobiologia 3 op tai
BIO-221 Kandidaattiseminaari: fysiologia ja neurotiede 3 op
Kirjallisuus, 5 op (valitse oman tieteenalan kirjallisuuskuulustelu)
BIO-206 Kirjallisuus, ekologia ja evoluutiobiologia 5 op
BIO-207 Kirjallisuus, fysiologia ja neurotiede 5 op
BIO-208 Kirjallisuus, perinnöllisyystiede 5 op
BIO-209 Kirjallisuus, kasvitiede 5 op
BIO-210 Kirjallisuus, mikrobiologia 5 op
Kestävyys ja vastuullisuus, 5 op Pakollinen, 3 op
SUST-001 Kestävyyskurssi 3 op Vaihtoehtoiset, 2 op
BIO-519 Sienituntemus 2 op
ENV-101A Maailman ympäristöongelmat ja niiden ratkaiseminen, tutustumiskurssi 2 op tai muu kestävyys- ja vastuullisuusteemainen opintojakso, esimerkiksi Biodiversiteettiverkoston tai UnaEuropan tarjoamia opintoja.

Tieteenalakohtaiset aineopinnot, 25 op (valitaan yksi kokonaisuus seuraavista)
BIO-300 Ekologia ja evoluutiobiologia, opintokokonaisuus
BIO-400 Fysiologia ja neurotiede, opintokokonaisuus
BIO-500 Kasvitiede, opintokokonaisuus
BIO-600 Perinnöllisyystiede, opintokokonaisuus
BIO-700 Mikrobiologia, opintokokonaisuus
Työelämä ja asiantuntijuus, 10 op
BIO-001 Biologian asiantuntija 1 2 op BIO-012 Biologian asiantuntija 2 2 op BIO-013 Biologian asiantuntija 3 1 op BIO-005 Työelämäjakso 5 op
Tieto- ja viestintätekniikan valmiudet, 3 op DIGI-200A Opiskelijan digitaidot: orientaatio 2 op DIGI-200B Opiskelijan digitaidot: syventävät taidot 1 op tai
DIGI-400A Opiskelijan digitaidot: orientaatio (ruotsinkielinen) 2 op DIGI-400B Opiskelijan digitaidot: syventävät taidot (ruotsinkielinen) 1 op
Viestintä ja kieliosaaminen, 10 op KK-AIAKTE2OP Akateemiset tekstitaidot (suomi) 2 op BIO-007 Puheviestintä 1 op tai
KK-MOAKSK2SP Akademiskt skrivande (svenska) 2 op KK-MOAKKO1SP Akademisk kommunikation (svenska) 1 op
Toinen kotimainen kieli, 3 op Jos koulusivistyskieli on suomi:

KK-RUBIYM Toisen kotimaisen kielen suullinen taito, ruotsi (CEFR B1) 2 op KK-RUERI Toisen kotimaisen kielen suullinen taito, ruotsi (CEFR B1) (erilaiset oppijat) 2 op KK-RUKIRJ Toisen kotimaisen kielen kirjallinen taito, ruotsi (CEFR B1) 1 op
Jos koulusivistyskieli on ruotsi:
KK-FINMU Toisen kotimaisen kielen suullinen taito, suomi (CEFR B1) 2 op
KK-FINSK Toisen kotimaisen kielen kirjallinen taito, suomi (CEFR B1) 1 op
Vieras kieli, 4 op
KK-ENBIYM Academic and Professional Communication in English 1 & 2 (CEFR B2)
KK-ENERI Academic and Professional Communication in English 1 & 2 (CEFR B2) (erilaiset oppijat) 4 op tai muu vieras kieli, jossa CEFR-taso on vähintään B1 4 op
Vapaasti valittavat opinnot 35 op

Onneksiolkoon! Oletaloittamassa opintojasimolekyylibiotieteiden koulutusohjelmassa,jostavalmistut luonnontieteidenkandidaatiksi. Molekyylibiotieteiden(tuttavallisemmin”mole”)monipuolisetopinnottarjoavatväylänerikoistuauseille eribiotieteenaloille,japääset sukeltamaanmolekyyli-jasolutason maailmaan.Opinnotsuoritettuasi osaatkuvaillabiokemiallisiareaktioita,solumekanismejajaerilaisten organismienfysiologiaa.Hallitset biotieteellisentutkimuksenperustyökalujenkäytönjaosaatsoveltaa tietotaitojasikäytännössä.Ajatusmaailmasikypsyytieteelliseenja lähdekriittiseenajatteluunsekä ongelmanratkaisukykyyn.Sinustakehkeytyykasvavanalanmoniosaaja,jokavoitulevaisuudessatyöllistyäesimerkiksi tutkimusryhmiin, valtionlaitoksiintai alanyrityksiin.
Molenperusopinnotkattavatlaajasti biotieteidenalanaihepiirit,jotka antavatvalmiudetsyventyälukuisiin erimaisteriohjelmiin,kiinnostivat sinuasittenmikro-organismit,kasvit, eläimettaiihminen.Omankiinnostuksesimukaanvoitkinvalitahyvin vapaastivalinnaisiaopintojatäydentämääntutkintoasiesimerkiksikemiasta,farmasiasta,tietojenkäsittelytieteestätaielintarviketieteistä.Koska opintojensuunnittelussaonvapautta, mahdollisuuksienlisäksiseasettaa myösvastuuta.Opintojenlopullisestasuunnittelustavastaaopiskelija itse,silläopintosuunnitelmaaeiole määrättytarkasti,muttapakolliset kurssitonoltavasuoritettuina.Myös kurssiensuorittamisjärjestysvoi vaihdella,javalinnanvaraaon kohtalaisesti.Opinnotonkinhyvä suunnitellaajoissaitsenäisestitai ohjaavanopettajankanssa.Ensimmäinenvuosionkuitenkinrakennettusuhteellisenvalmiiksi peruskursseineen,jotkaesitelläänseuraavallaaukeamalla. Peruskurssitonhyväsuorittaa ensimmäiseksi,silläneovat useinesitietovaatimuksinasyventävillekursseille.




Kurssiensuoritustavatvaihtelevat perinteisistäluentokursseistalaboratorioharjoituksiinjaohjelmointiin, elipääsetopintojenaikanakirjoittamaanmuistiinpanojajalukuisia esseitäsekätyöskentelemäänkäsilläsijalaittamaannäppäimistönlaulamaan.Osakursseistatarjoaavaihtoehtoisiasuoritustapoja,muttauseimmitensuoritusmerkinnänsaaminen edellyttääuseita erilaisia osatehtäviä, kutenesseitä,minitenttejä,esitelmiä, ryhmätöitätaisimulaatioita.Onkin hyväpysyäskarppinakurssinensimmäiselläluentokerralla,jakirjata kaikkideadlinetmuistiin.Onmyös hyväpitäämielessä,ettävaikka kurssillaolisiosasuorituksia,on myöstenttiävartentehtäväitsenäi-
Molekyylibiotieteetsaattavatkuulostaaalastajakoulutusohjelmastatietämättömälletieteisfiktiolta.Keskeisiä tieteenalojamolellaovatgenetiikka, biokemia,mikrobiologia,biotekniikkajabioinformatiikka.Moleltasaat myösvalmiudeterikoistualääketieteellisilletaifarmakologisillealoille (esim.lääkekehitykseen),ravitsemustieteisiinjamonillemuillebiotieteidenaloille,kutenneurotietei-
Molellaeivalitatiettyäopintosuuntaa,vaankaikkinoudattavatsamaa opinto-ohjelmaa.Perus-jaaineopinnoissaonmelkovähänmuunneltavuutta,muttakoulutusohjelmaan sisältyy35opintopistettävapaavalintaisiaopintoja,jotkavoit valitatäysinvapaastisinua kiinnostavistaaiheista.Myös tukiaineissa(kemia,matematiikka,tilastotiede...)Onenem-
Genetiikka -tutkiieliöidenperimää eligenomia,senperiytyvyyttäja geenienmuutoksiaelimutaatioita
Biokemia -tutkiielävissäorganismeissaesiintyviäkemiallisiaja fysikaalis-kemiallisiaprosessejasekä biomolekyylejä
Mikrobiologia -tutkiimikroskooppisiaeliöitä,kutenbakteereita, arkeoneja,viruksia,sieniä,leviäja alkueliöitä,janiidenominaisuuksia
Biotekniikka -biologistenprosessienhyödyntäminenteollisiinja muihintarkoituksiin,erityisesti mikro-organismiengeenimanipulointi antibioottien,hormonienjayms. tuotantoon
Bioinformatiikka -kerääjaanalysoi monimutkaistabiologistadataa, kutengeenisekvenssejä,algoritmien jaohjelmienavulla
Ravitsemustiede -tutkiiruokavaliotajasenvaikutuksiaterveyteen sekätieteellisenymmärryksen soveltamistaravitsemuksen kehittämiseen
Neurotiede -monitieteellinenala (mm.neurologia,neurokemiaja neuropsykologia),jokatutkiiaivojen jahermostonrakennettajatoimintaa
Farmakologia -Lääketieteenhaara, jokakäsitteleelääkkeidenkäyttöä, vaikutuksiajatoimintatapoja.
Määritelmientekemisenapunakäytettiin MOTOxfordDictionaryofEnglishsanakirjaa.
tulee
genetiikankursseillatutuksi!
Tälläaukeamallaonesiteltymolekyylibiotieteidenkandiohjelmanensimmäiselleopiskeluvuodellesoveltuviakursseja.
Biokemia,5op
Tälläalkusyksynluentokurssillaperehdytäänbiokemianperusteisiin.Opitmuun muassaperusasiatsolunmakromolekyyleistä,kutennukleiinihapoista, hiilihydraateistajaproteiineistasekäsolun biokemiasta.Myösbiokemiaanliittyvät fysikaalisetjakemiallisetperiaatteet samoinkuinaiheeseenliittyvä terminologiatulevattutuksi.
Mikrobienmonimuotoisuus, rakennejatoiminta,5op
Näillämikrobienjännittäväänmaailmaan keskittyvilläluennoillaopitmikroorganismienpääryhmät,mikrobien aineenvaihdunnanjalisääntymisen perusteetsekäsen,kuinkamikrobit vaikuttavataineidenkiertoon.Kurssilla tutustutaanmyösmikrobienkasvatukseen,niidensolutasonrakenteeseen, mikrobienbiotekniseenhyödyntämiseenja niidentutkimiseen.Oppimistatestataan viikoittaistenkirjoitustehtävienavulla.
Mikrobitjaihminen,5op
Mikrobitjaihminen-kurssitutustuttaa niihinvuorovaikutuksiin,joitamikrobien jameidänvälilläon.Opiskeletmm. mikrobienvaikutuksiaihmistenterveyteen,normaalinmikrobiflorantoimintaa, immunologianperusteitasekämikrobien taudinaiheuttamismekanismejajaniistä johtuviatauteja.Perehdytlisäksimyös mikrobeihinliittyviinkliinisiindiagnostiikka-jatutkimusmenetelmiin.
Tieteellisenlaskennanperustaidot, 5op
Tieteellisenlaskennankurssillaopetellaan tieteellisenanalyysinjadatankäsittelyn kannaltaoleellisiaohjelmoinninperusteita sekäUnix-ympäristönkäyttöä.Lisäksi perehdytäänR-kieleensekäR-ohjelmistossatapahtuvaandatananalyysiinja visualisointiin.Tämänkurssinaikana pääsetharjoittelemaannäitäasioita käytännössätietokoneharjoituksiatekemälläsekäkurssinasioitatestaavassa lopputyössä.
Molekyylibiotieteiden johdantokurssi,2op Tälläjohdantokurssillakandiohjelmanhenkilökuntajaeri tutkimusalatkäyvätesittäytymässämolenfukseille. Kurssinaikanaopittuntemaan,ketkämolekyylibiotieteidenalallaopettavatja tutkivatjamillaisiaurapolkuja tälläalallaontarjolla.Lisäksi perehdytopiskelutaitoihinja tieteelliseentiedonhakuun.
Opiskelijandigitaidot,3op Tälläkurssillapyritäänhuolehtimaansiitä, ettäkaikkiopiskelijathallitsevatopiskeluissaantarvitsemansadigitaidot,kuten tekstinkäsittelyn,taulukko-ohjelmat, tiedonhaunjamuuttietotekniikan perusteet.Kurssionpakollinen kaikillealempaakorkeakoulututkintoasuorittaville.
Solubiologia,5op
Solubiologiankurssillakäydäänläpieukaryoottisolujen rakennetta,soluelimiä,solun tukirankaa,kalvoliikennettäja solujenvälistäviestintää. Luennoillaperehdytlisäksi erilaisiinsolubiologisiintekniikoihinjaniihinliittyvienlaboratoriokokeidenteoriaansekäkasvi-ja eläinsolujenenergiaaineenvaihduntaan.
Genetiikanperusteet,5op



Genetiikanperusteissanimensämukaisestitutustutaanperinnöllisyystieteen perusperiaatteisiin.Tällaisiaovat mm.DNA:n,kromosomienja geenienrakennejatoiminta, geneettinenmuuntelu,periytyminen,epigenetiikkaja geenisäätely.Tämänkurssi antaahyvänpohjankaikille myöhemmillegenetiikkaan liittyvillekursseille.








Molekyylibiotieteiden






harjoitustyökurssi,5op Biotieteilijöidenensimmäisellä labora-toriokurssillaharjoitellaan laboratoriossatoimimista,turvallistatyöskentelyäjatarpeellisia perustekniikoitasekätyövaiheidenjatulostendokumentointia. Syksylläjärjestettävässäensimmäisessäosiossaopiskellaan biokemiaanjayleiseenlabratyöskentelyynliittyviäasioita, kutenpipetinkäyttöä,spektrofotometriaa,liuostenvalmistustaja geeliajoa.Talvellapidettävässä toisessaosassapuolestaantutustutaan mikrobiologiseentyöskentelyyn,kuten aseptisiintyötapoihin,mikrobienkasvatukseen,mikroskopointiinjamikrobigenetiikkaan.
Kasvi-jaeläinfysiologian perusteet,5op
Tälläkurssillaopiskellaan kaikillebiotieteilijöilleoleellisia perusasioitasekäkasvi-että eläinfysiologiasta.Kasviosuudessatutustutaanmm.kasvien anatomiaan,fotosynteesiin, kasvienvesi-jaravinnetalouteen,kasvihormoneihinja kasvienelinkiertoon.Eläinfysiologianosuudessapuolestaan perehdytäänesim.eläintenrakenteenjatoiminnanperusteisiin,hermo-, aistin-jalihasfysiologiaansekä verenkiertoonjahengitykseen.

Atomit,molekyylitjavuorovaikutukset,5opjaEnergia,reaktiivisuusjakemiallinen tasapaino,5op
Näilläkahdellayliopistokemian peruskurssillaopitbiotieteidenkin kannaltaoleellisetperustiedot, kutenkemiallisetsidokset, atomienjamolekyylienrakenteen,lämpö-jasähkökemianja olomuodot.Lisäksiperehdyt mm.reaktionopeuteen,kemialliseentasapainoon,happoihinja emäksiinsekätermodynamiikkaan.Kummallakinkurssillaon
luentojenlisäksinetissätehtäviälaskuharjoituksia.Näidenkurssienjälkeen hallussasiovattarpeellisimmatkemiallisetlaskukaavatjaniillälaskeminensekä ymmärryskemiallisistalainalaisuuksista.
Geenitekniikka,2+5op Geenitekniikankurssijakautuukahteen osaan.Aluksipidetäänluennot,joilla käydäänläpierilaisiageeniteknisiä menetel-miäjaniidenteoriaa.Myöhemminlabraosuudessapääseesitten harjoittelemaannäitätekniikoita,kuten geeninsiirtovektorienjakatkaisuentsyymienkäyttöä,PCR:ääjakloonausta, käytännössä.
TilastotiedeI&II:Tilastollisen ajattelunjamenetelmienperusteet,2+3op Tilastotieteenperuskurssitantavateväät tilastolliseenajatteluunsekätilastojen tulkintaanjatilastollistentestientekemiseen.Luennoillakäydäänläpieri-laisia tilastollisiatestejäsekäsitä,kuinka tilastotiedettävoidaanhyödyntää biotieteellisessätutkimuksessajadatan analysoinnissa.Tietokoneharjoituksissa sovelletaanteoriaakäytäntöönja harjoitellaantilasto-ohjelmankäyttöä.
Molekyylibiotieteidenjafarmasian orgaanistakemiaaA,5op
Farmasianjärjestämälläorgaanisenkemianperuskurssillatutuksitulevatorgaanisenkemiantavallisimmatreaktiotja niidenperusperiaatteet.Läpikäytäviä reaktioitajareagenssejaonrunsaasti, jotenkurssinluennoillakannattaaperehtyäteoriaanhuolellisesti.Lisäksion hyvinsuositeltavaaosallistualaskuharjoituksiin,silläniidentehtävissätreenataanrunsaastireaktiomekanismien kirjoittamistajapäättelemistä.
Kumpulankampuksellajärjestetäänkemiankandiohjelmaankuuluvaorgaanisenkemianperuskurssi,jokavoi soveltuajoillekinparemminkuintämä farmasiankurssi.Kumpulanorgaaninen kemiaonvapaamminsuoritettavissaja kandiohjelmanopettajatovatkemianalan kärkeä.
Maisterivaiheessasaatvalitaerikoistumisalasiuseistabiotieteisiinliittyvistä maisterivaihtoehdoista,joistayleisimmätolemmeesitelleettässä.Kannattaa ollakuulollaesimerkiksijohdantokurssilla!Voitjokandivaiheessalähteä suuntautumaankohtikiinnostavaaaihetta,muttaälähuoli,vaikkaetvieläosaa päättääkiinnostavaaalaa-kandinaikana tutustuumonipuolisestierilaisiinsuuntautumisvaihtoehtoihin.
Biologianopettaja
Molekyylibiotieteilijäkinvoihakeaaineenopettajankoulutukseenjavalmistua biologianopettajaksi.Toiseksiopetettavaksiaineeksisuositellaankemiaatai maantietoa.Tarkemminopettajanpestistävoitlukeabiologiankoulutusohjelmankohdalta!Mikäliopekoulutuson tavoitteenasi,saatnoudattaamolekyylibiotieteidenopiskelijanahiemanerilaistakandiohjelmaa,jotenaikainen herääminenopettamisenjaloontaitoon onkieltämättävalttia(muttaeivälttämätöntä).
Genetiikkajamolekylaariset biotieteet(GMB)
Genetiikkajamolekylaarisetbiotieteet onmaisteriohjelmistaensisil-mäyksellä kaikistaenitenmolekyylibiotieteiden kandiopinnoilleräätälöitymaisteriohjelma.GMB-maisteriohjelmassaonmahdollisuuserikoistuabiokemiaanjarakennebiologiaan,genetiikkaanjagenomiikkaan,solu-jakehitysbiologiaantai molekulaaristenjaanalyyttistenterveydenbiotieteisiin.Genetiikanopiskelijanasaattarkintamahdollistatietoasiitä, kuinkageenit,solutjakudoksetmuodostavattoimiviayksiköitäjaylläpitävät elämää.Tärkeitätutkimusaiheitaovat soluntukirangandynamiikka,solujen viestintä,kantasolutsekäkehitysbiologia hermostonjaevoluutionkannalta. Molekulaaristenjaanalyyttistenterveydenbiotieteidensuuntaustarjoaaopintojauusistaaiheista,kutenbiopankeista, yksilöllisestälääketieteestäsekäuusimmistaanalyysimenetelmistä.

Mikrobiologiaja mikrobibiotekniikka(MMB) Mikrobiologiantieteenalavalottaamikrobienmerkitystäelämällejaympäristöllemaailmanlaajuisesti.Mikrobiologianjamikrobibiotekniikanmaisteriohjelmassakeskitytäänmikrobienbioteknologisiinsovelluksiinsekätutkimusmenetelmiin,joillatutkitaanviruksia, bakteereitajamuitamikrobeja.Mikrobientutkiminenjasitämyötäsoveltaminentarjoaauuttatietoajotunnetuista luonnonilmiöistäsekämoniasovellusmahdollisuuksiatulevaisuudenongelmienratkaisuihin.Voitollamukana oppimassajamyöhemminkehittelemässämaailmaamullistaviatekniikoitaja korjaamassaoikeitaongelmiakäyttäen pienenpieniämuttaniinkovinmonimuotoisiajakäyttökelpoisiaeliöitä.

Agaroosigeelilläajetun DNA:ntarkasteluaUVpöydällä




Translationaalinenlääketiede (Transmed)
MeilahdenkampuksellaLääketieteellisessätiedekunnassaopetettavaanTransmedinmaisteriohjelmaanvoihakea erillishaussa.Ihmistensairauksientutkimukseenjatutkimustapoihinkeskittyvässäkoulutusohjelmassavoivalitaviidestäeriopintosuunnnasta:syöpä,regeneratiivinenlääketiede,metabolisetsairaudet,neurotiedetaipoikkitieteellinen translationaalinenlääketiede.Transmedistäsaakliinistänäkökulmaaopintoihinsakansainvälisessäympäristössä.
KumpulankampuksenMatemaattisluonnontieteellisentiedekunnanLife ScienceInformaticssopiibioinformatiikastasyvemminkiinnostuneille.Kandivaiheessaonsuoritettavamatematiikan,tietojenkäsittelytieteidentaitilastotieteenopintokokonaisuus.Bioinformatiikassakeskitytääntilastolliseenja matemaattiseenmallintamiseensekä suurienbiologistenaineistojenanalysointiinalgoritmienavulla.LSI-maisteriohjelmassavoierikoistuabioinformatiikanjasysteemilääketieteenlisäksi
myösbiomatemaatiikkan,biostatiikkaan taiekologianjaevoluutiobiologian informatiikkaan.

Muitamaisteriohjelmia
Molekyylibiotieteistävoisuuntautua moniinbiologiankandiohjelmanosuudessajoesiteltyihinmaisteriohjelmiin, kutenneurotieteisiin,ekologiaanjaevoluutiobiologiaansekäkasvitieteisiin. Näidenlisäksivalittavissaonmyös ravitsemus-,ravinto-jaelintarviketieteet,maatalous-jametsätieteet,sekä villinäkorttinakulttuuriperinnönmaisteriohjelmanarkeologianopintosuunta!
Maisteriohjelmillasaattaaollajoitain hakuvaatimuksia,muttaneeivätole mitenkäänmahdottomia.Monisisällyttääkiinnostavanalankurssejahelposti valinnaisiinopintoihin.Kanditutkintoon kuuluvienvalinnaistenopintojenavulla onmuutenkinhyväselvittääkiinnostuksenkohteitajasitämyötenkartoittaa mahdollisiamaisteriohjelmiaomaa tulevaisuuttaajatellen.Voitlukeavielä tarkemminmaisteriohjelmistamyös Helixry:njärjestölehtiVapaanRadikaalinnumerosta1/2021LilliRasilankirjoittamastaartikkelista,jokatoimiapuna tämänkintekstinkirjoittamisessa!


Lukuvuosi jakaantuu neljään opetusperiodiin, joista kukin kestää seitsemän viikkoa. Periodeja on kaksi sekä syys- että kevätlukukaudella.
Lukuvuodessa on kolme intensiivijaksoa: ennen ensimmäistä ja kolmatta periodia sekä neljännen periodin päätteeksi. Intensiivijaksolla järjestetään esimerkiksi orientaatiojaksoja (fuksien orientaatioviikko!) sekä mahdollisesti erilaisia kursseja tai ylimääräisiä tenttejä. Opetusta siis ei ole välttämättä tällä jaksolla, vaan kurssit alkavat yleensä periodin alussa.

Huom! Tarkistathan kurssien aikataulut Sisusta tai kurssin vetäjältä. Sisun kurssihaku
Avoin yliopisto
Monesta peruskurssista on sekä Helsingin yliopiston että Avoimen yliopiston järjestämä kurssi. Jos jokin mielenkiintoinen kurssi ei mahdu lukujärjestykseesi, kannattaa tutkia, löytyykö sama kurssi Avoimen yliopiston tarjonnasta kesällä. Avoimen yliopiston kurssit erottaa AY-kurssikoodi (esim. MOLE-211 ja AYMOLE-211). Avoimen yliopiston kesäopinnot ovat läsnä oleville HY:n opiskelijoille maksuttomia, joten heidän kurssitarjontaansa tutustumista voi lämpimästi suositella.
Avoin yliopisto
Kandista maisteriin
BYTDK:ssa opiskelijoilla ei ole suoraa optiota maisteriohjelmiin, vaan näihin tulee aikanaan hakea ja täyttää määrätyt kriteerit. Maisteriohjelmien haku- ja kelpoisuusehdoista on hyvä olla perillä jo suhteellisen varhaisessa vaiheessa opintoja. Kandiopiskelija voi ilmoittautua myös maisteritason kursseille, jos kokee suoriutuvansa niistä.
Jatkaminen maisteriohjelmaan
Lisää kursseja!
Tiedekuntien tarjoamat valinnaiset opinnot
Biosfäärin kurssiopas
Biodiversiteettikoulutusverkosto
Joustava opinto-oikeus (JOO)
I opetusperiodi
BIO-001 Biologian asiantuntija 1 (jatkuu läpi lukuvuoden)
BIO-101 Eliökunnan evoluutio
BIO-102 Eläin- ja kasvikunnan rakenne
KEK110 Kemian perusteet
ME-004 Tilastotiede I (järjestetään myös 4. periodissa)
MOLE-210 Tieteellisen laskennan perustaidot ja laskuharjoitukset
II opetusperiodi
BIO-201 Molekyylit ja solut
MOLE-102 Genetiikan perusteet
MOLE-103 Mikrobien monimuotoisuus
MOLE-212B Molekyylibiotieteiden harjoitustyökurssi (biokemia)
III opetusperiodi
BIO-104 Ekologian perusteet
BIO-202 Kasvi- ja eläinfysiologian perusteet
MOLE-212D Molekyylibiotieteiden harjoitustyökurssi (mikrobiologia)
IV opetusperiodi
BIO-103 Eliöiden monimuotoisuus
ME-004 Tilastotiede I (järjestetään myös 1. periodissa) Ekologian kenttäkurssien luennot
Kesä 2025
BIO-204 Ekologian kenttäkurssi - elinympäristöt ja lajisto
BIO-301 Tutkimuksen teon perusteet
I opetusperiodi
MOLE-010 Molekyylibiotieteiden johdantokurssi (jatkuu 2. periodissa)
MOLE-101 Biokemia
MOLE-210 Tieteellisen laskennan perustaidot ja laskuharjoitukset
KEK101 Atomit, molekyylit ja vuorovaikutukset
ME-004 Tilastotiede I (järjestetään myös 4. periodissa)
II opetusperiodi
MOLE-010 Molekyylibioteiteiden johdantokurssi (jatkoa 1. periodista)
MOLE-102 Genetiikan perusteet
MOLE-103 Mikrobien monimuotoisuus
MOLE-212B Molekyylibiotieteiden harjoitustyökurssi (biokemia)
KEK103 Energia, reaktiivisuus ja kemiallinen tasapaino
FARM-302 Molekyylibiotieteiden ja farmasian orgaanista kemiaa A
III opetusperiodi
BIO-202 Kasvi- ja eläinfysiologian perusteet
MOLE-212D Molekyylibiotieteiden harjoitustyökurssi (mikrobiologia)
MOLE-213A Geenitekniikka luennot
IV opetusperiodi
ME-004 Tilastotiede I (järjestetään myös 1. periodissa)
MOLE-104 Solubiologia
MOLE-205 Mikrobit ja ihminen
MOLE-213C Geenitekniikka harjoitustyöt
– Kaksikielisen tutkinnon avulla parannat kielitaitoasi opintojen aikana
Haluatko osata ruotsia paremmin kuin muutaman fraasin verran?
Kaksikielinen tutkinto on loistava tilaisuus parantaa omaa ruotsin kielen taitoa! Kaksikielisessä tutkinnossa opiskelija suorittaa vähintään 60 opintopistettä ruotsiksi. Ruotsinkieliset opinnot voivat koostua oman alan opintojen lisäksi esim. sivuaineopinnoista ja kielikursseista.
Kuka voi suorittaa tutkinnon?
Kaksikielisen tutkinnon eli KaTun voivat suorittaa kaikki biologian, molekyylibiologian ja ympäristötieteiden tänä syksynä aloittavat fuksit äidinkielestä riippumatta.
Mitä tutkintoon vaaditaan?
Tutkinnon suorittamiseksi kolmasosa kandidaatintutkinnon opinnoista (60 op) tulee suorittaa ruotsiksi, kolmasosa suomeksi ja viimeinen kolmasosa millä tahansa kielellä. Jotta kurssi lasketaan toisella kotimaisella suoritetuksi, kurssin opetuskielen on oltava toinen kotimainen kieli. Myös tentti on kirjoitettava tällä kielellä. (Sitä ei kuitenkaan kannata pelätä, koska tenteissä saa käyttää sanakirjaa eikä kielioppivirheistä rokoteta.) Kielivaatimukset koskevat sekä suomen- että ruotsinkielisiä opiskelijoita.
Mitä kursseja tarjotaan?
Opintopistepotin voi koostaa oman alan kursseista, sivuaineopinnoista ja kielikursseista. Ruotsinkielisten kurssien valikoima on paljon kapeampi kuin suomenkielisten, mutta tarjontaa löytyy silti. Tavallisten luentokurssien lisäksi tarjolla on ekskursioita ja kenttäkursseja eikä muiden tiedekuntien tarjontaa kannata unohtaa.
Suomenkielinen biologia
Ruotsinkieliset opinnot painottuvat ensimmäiseen vuoteen, jolloin kursseja on parhaiten saatavilla.
Svenskspråkig biologi
Första året studerar man på svenska och efter det har man största delen av studierna på finska.
Molekyylibiotieteet ja ympäristötieteet
Ruotsinkielisiä kursseja suoritetaan muiden opintojen lomassa yleensä koko kandidaatintutkinnon ajan.
Miksi ihmeessä?
KaTun kautta löytää uusia kavereita ja verkostoituu yli kielirajojen. Kielitaito kohenee opintojen ohessa, mikä on iso etu työelämässä. KaTu on mainio tapa oppia ammattisanasto kahdella kielellä. Monen mielestä parasta on kuitenkin itsensä voittaminen ja ryhmässä syntyvä yhteishenki.
Pitääkö olla kaksikielinen?
Ei suinkaan! KaTun tarkoitus on tarjota mahdollisuus oppia kieltä mahdollisimman matalalla kynnyksellä. Tutkinnon aikana kielitaito vahvistuu huimasti. B-kieliopinnoilla pärjää kyllä ja kielitaito kehittyy yllättävän nopeasti. Lähtötasosta riippuen alussa vaaditaan enemmän töitä, mutta vieraalla kielellä opiskeluun tottuu aika äkkiä. Täydellistä kielitaitoa ei vaadita missään vaiheessa opintoja.
Millaista tukea saan?
Tukea opintoihin saa kaksikielisen tutkinnon vastuuopettajilta, kielikeskuksen räätälöidyiltä kursseilta, KaTu-tuutoreilta sekä tietysti muilta KaTu-opiskelijoilta. Opettajat ovat yleensä varsin ymmärtäväisiä ja sanakirjaa saa aina käyttää tenteissä. Vuoden mittaan järjestetään useita KaTu-opiskelijoille suunnattuja tapahtumia, joissa on helppo tutustua muihin yli kielirajojen.
Entä jos olen epävarma?
Tutkintoon ilmoittautuminen ei sido mihinkään. KaTua voi tulla kokeilemaan ja sen saa halutessaan jättää kesken koska tahansa.
Mistä saan lisää tietoa?
KaTua esitellään orietoivalla viikolla infotilaisuudessa. Tuutoreihin (katso tuutoriesittely) saa olla yhteydessä jo aiemmin, jos mielessä kutkuttaa kysymyksiä.
Gäller det här mig om jag studerar biologi på svenska sidan?
Absolut! Det är lika möjligt för dig också. Det är en enorm fördel att studera på både svenska och finska. Utöver att utveckla dina finska språkkunskaper så öppnar en tvåspråkig examen fler dörrar på jobbmarknaden. Första året får du i alla fall studera på svenska och du har tid att fundera på saken. Det lönar sig ändå att redan under första året delta i olika TvEx-evenemang som tutorerna ordnar för att lära känna finskspråkiga medstuderande.
Hejsan!
Terveiset meiltä KaTu/TvEx-tuutoreilta elikkä kaksikielisen tutkinnon tuutoreilta. Me ollaan täällä auttamassa teitä kaksikielisten opintojen kanssa, så att studera på två språk ska bli så roligt som möjligt :) KaTu-opinnot ovat mainio keino paitsi tulla sen toisen kotimaisen kielen mestariksi, myös löytää uusia kavereita. Vi har många roliga evenemang under läsårets gång, hoppas vi ses där! Aiempi kielitaito ei ole niin tärkeää - med tillräcklig motivation kan vem som helst lära sig! Joten jos kiinnostus heräsi, tulkaa vain rohkeasti TvExiin mukaan! Meitä voi aina tulla nykäisemään hihasta jos on kysyttävää tai muuten vain tarvitsee kaksikielistä vertaistukea.
Marcus Wallin marcus.wallin@helsinki.fi
Onni Borg onni.borg@helsinki.fi
Biologiset asemat tarjoavat opiskelijoille niin gradu- ja työpaikkoja kuin myös unohtumattomia kenttäkursseja, joista on kaikille aloille hyötyä! Helsingin yliopistolla onkin kolme kotimaista asemaa, jonka esittelyt ovat alla.
Pääjärven rannalla sijaitseva Lammin biologinen asema on fuksien kesäkoti. Vuodesta toiseen fuksit ovat saapuneet asemalle täynnä opiskeluintoa ja viihtyneet Järvi-Suomen hulppeissa maisemissa, jossa tektoniset ja jääkauden prosessit ovat muodostaneet Suomen viidenneksi syvimmän järven ja kristallin kirkasta lähdevettä pulppuavia harjuja.
Lammin kenttäkurssien aikana ei vain pääse tutustumaan asemaa ympäröivään monimuotoiseen luontoon vaan myös usein solmitaan kaverisuhteita, jotka monesti kestävät koko eliniän. Näin todistivat Lammin fuksit kesäkurssilta 1955, jotka juuri järjestivät kurssitapaamisen 60 vuotta myöhemmin asemalla!


Ensimmäisen opiskelukesän aikana fukseilla on mahdollisuus osallistua Ekologian kenttäkurssiiin ja Ekologisen tutkimuksen kenttäkurssiin kesäkuun alusta heinäkuuhun. Ekologian kenttäkurssilla pienryhmät tutustuvat Etelä-Suomen maa- ja vesiekosysteemien tärkeimpiin elinympäristöihin ja niiden kasvi- ja eläinlajistoon. Ekologisen tutkimuksen kenttäkurssilla on opiskelijoiden vuoro suunnitella ja toteuttaa omia tutkimuksia ja jopa julkaista niitä. Valmistuttuaan opiskelijat usein toteavat, että kaikista käymistään kursseista juuri ensimmäisen vuoden kenttäkursseista he olivat oppineet kaikkein eniten.
Kesäkurssien aikana opiskelijat majoittuvat aseman opiskelija-asuntolaan. Aktiivisen opiskelun ohella asema tarjoaa erilaisia vapaa-ajan aktiviteettejä kuten lentopalloa, frisbeegolfia ja mölkkyä. Jos on hieno sää, kannattaa lainata aseman kanootteja tai soutuveneitä ja lähteä Pääjärvelle nauttimaan kesäillasta. Suosituin aktiviteetti on kuitenkin saunominen aseman hienossa rantasaunassa, vaikka vuodesta 2016 lähtien kova kilpailija on ollut myös aseman laavu ja grillipaikka Pääjärven rantamaisemissa.
Tvärminnen eläintieteellinen asema: Saariston helmi

Tvärminnen eläintieteellinen asema on Hankoniemen upeassa saaristomaisemassa sijaitseva kenttäasema. Tvärminne on tullut tutuksi lukuisille opiskelija- ja tutkijasukupolville, sillä asema perustettiin jo vuonna 1902. Tvärminnen toiminta suuntautuu rannikkoalueelle ja saariston eri vyöhykkeisiin – niin maan päällä kuin veden alla. Tvärminnessä järjestettäviin kenttäkursseihin lukeutuvat sekä yleisluonteiset, orientoivat kurssit että erikoiskurssit, jotka keskittyvät eri eliöryhmiin tai elinympäristöihin. Asemalla järjestetään myös tutkimussukelluskursseja.
Tvärminnen luonto tarjoaa opiskelijalle ainutlaatuisia kokemuksia. Maaperä on kalkkipitoista ja ilmasto Suomen mittakaavassa leuto; aseman lähiympäristöstä löytyy pähkinä- ja muita lehtotyyppejä, sekä näille ominaisia kasvilajeja. Saariston eri vyöhykkeet ovat helposti saavutettavissa jopa soutuveneellä. Vedenalainen luonto on erittäin monimuotoinen, ja se on normaalin kurssiopetuksen ohella koettavissa snorklaamalla ja sukeltamalla. Tästä kiinnostuneiden on syytä olla yhteydessä kurssin vetäjään sekä aseman sukelluspäällikköön. Aseman ympäristö koostuu luonnonsuojelualueesta, johon kuuluu n. 450 ha vesialueita ja 150 ha maata, ml. lukuisat saaret. Rauhoitusstatus on omiaan säilyttämään arvok-
kaita luontoarvoja opetuksen ja tutkimuksen käyttöön.
Tvärminnen toiminta on vilkasta läpi vuoden, ja kenttäkausi on varsin pitkä – aina huhtikuusta loppusyksyyn. Vilkkaimpina kuukausina asemalla asuu satakunta henkilöä – niin opiskelijoita kuin tutkijoita. Runsaasta kävijämäärästä huolimatta yhteisöllisyys on Tvärminnessä valttia. Kurssien omien ohjelmien lisäksi aseman ruohokentällä voi pelata esim. jalkapalloa, asuntoloissa on yhteisiä seurustelutiloja jne. Oman mausteensa aseman toimintaan tuo kansainvälisyys – noin kolmannes käyttäjistä tulee ulkomailta. Omaa rauhaa kaipaaville on edullisella vuokralla tarjottavana kajakki sekä aseman luontopolku ja muut kulkureitit.
Asemalla asutaan pääasiassa 2 hengen huoneissa, ja kenttäasemalla oltaessa suihku- ja wc-tilat ovat perheasuntoja lukuun ottamatta käytävillä. Tilava rantasauna meren äärellä lämpenee keskiviikkoisin ja lauantaisin (yleiset saunavuorot), sekä kurssien tai muiden ryhmien tilauksesta muulloinkin.
Kurssien ohella Tvärminne tulee tutuksi monelle opiskelijalle graduaikana, kesätyöntekijänä, tai aseman harjoittelupaikkojen kautta. Tervetuloa siis Tvärminneen!

Vuonna 1964 perustettu Kilpisjärven biologinen asema sijaitsee Suomen luoteisimmassa kolkassa lähellä kolmenvaltakunnan rajaa, vain 50 kilometriä Jäämerestä. Kilpisjärven erityislaatuinen ympäristö oli aseman perustamisen pääsyistä. Aluetta hallitsevat Skandien vuorijonoon kuuluvat suurtunturit kuten Saana (1029 m) ja Iso-Malla (942 m). Itse Kilpisjärvi sijaitsee 473 metriä merenpinnan yläpuolella. Vuorijono tarjoaa suotuisan kasvupaikan monille kalkkia tai erityisen karua kasvupaikkaa vaativille arktis-alpiinisille harvinaisille tunturikasveille kuten lapinalppiruusulle ja jääleinikille. Tunturikoivu on valtapuulaji, mutta suurin osa alueesta on puutonta paljakkaa.
Kilpisjärvellä elää pohjoisimman Fennoskandian tyyppieläimiä: tunturisopuli, tunturihaukka, tunturikihu, tunturipöllö, sepelrastas, sinirinta
jne. Pikkujyrsijöiden voimakkaat ja säännölliset 4–5 vuoden sykleissä tapahtuvat kannanvaihtelut vaikuttavat monien petolintujen pesintään sekä pikkupetojen, kuten kärpän ja lumikon, lisääntymiseen. Kilpisjärvellä esiintyy 16 perhoslajia, joiden levinneisyys rajoittuu Suomessa Luoteis-Lappiin. Suurharvinaisuuksiin kuuluu mm. pohjansiilikäs. Kirkasvetisissä järvissä, lammissa ja puroissa elävät siika, rautu, taimen ja harjus. Ilmasto on varsin arktinen: vuoden keskilämpötila on Manner-Euroopan alhaisimpia, vain -2,3°C. Kasvukausi on noin 100 vuorokautta, puolet lyhyempi kuin Etelä-Suomessa. Lumipeite on maassa keskimäärin lokakuun puolivälistä kesäkuun alkuun, ja Kilpisjärvi on jäätyneenä marraskuun lopulta kesäkuun puoliväliin. Kaamos kestää marraskuulta tammikuun alkuun ja yötön yö alkukesästä heinäkuun lopun tienoille. Aseman tutkimustoiminnan selkärangan muodostavat arvostetut, yli 50 vuoden ajalta luonnosta kerätyt pitkäaikaiset seuranta-aineistot. Modernit tilat tarjoavat tutkijoille ja opiskelijoille mainiot työskentelyolosuhteet. Asemalla järjestetään arktiseen luontoon liittyviä kursseja (mm. suba eli subarktinen ekologia), ja se on myös suosittu ja rauhallinen tukikohta opinnäytetöiden kirjoittajille. Kilpisjärvellä perustetun Suomen biotaiteen seuran kanssa asema edistää tieteen ja taiteen välistä yhteistyötä mm. Ars Bioarctica -laboratorionsa ja taiteilijaresidenssien avulla.

Yliopiston erillislaitoksilla keskitytään tutkimuksen tekemiseen, ja tutkijoiden lisäksi myös opiskelijat ovat tervetulleita! Yksiköt tarjoavat opetusta ja työharjoitteluja, potentiaalisia ohjaajia opinnäytetyöhön ja ehkäpä kesätöitäkin.
Luonnontieteellinen keskusmuseo
Luonnontieteellinen keskusmuseo eli Luomus tutkii luonnon monimuotoisuutta, ympäristön muutoksia sekä ihmisen ja luonnon vuorovaikutusta. Luomuksella on eläintieteen, kasvitieteen ja luonnontieteiden yksikkö. Luomuksen tutkimus perustuu kokoelmiin ja seuranta-aineistoihin. Kokoelmissa on yli 13 miljoonaa eläin-, kasvi-, sieni-, kivi- ja fossiilinäytettä. Bio- ja ympäristötieteen tiedekunnan opiskelijoilla on ilmainen sisäänpääsy yleisökohteisiin!
Lue lisää:
Luomuksen nettisivut
Lajitietokeskus
Pinkka - lajituntemuksen oppiympäristö


HiLife
HiLIFE on poikkitieteellinen elämäntieteiden instituutti. Tutkimusta tehdään yliopiston neljällä kampuksella ja Luomuksella. Elämäntieteisiin lukeutuvat biologia, lääketiede, ympäristötieteet ja myös fysiikka, kemia ja datatieteet.
HiLIFE koostuu kolmesta yksiköstä: Suomen molekyylilääketieteen instituutti (FIMM), Biotekniikan instituutti ja Neurotieteen tutkimuskeskus.
Lue lisää:
HiLIFE
FIMM
Biotekniikan instituutti
Neurotieteen tutkimuskeskus


Ei biologielämää ilman Symbioosia!
Symbioosi ry on kaikkien biologisten alojen opiskelijoiden ainejärjestö, joten toimintaan ovat tervetulleita kaikki perinnöllisyystieteilijöistä ekologeihin. Ainejärjestön tehtävänä on ajaa juuri sinun etuasi, ja myös varmistaa, ettei opiskelu käy liian rankaksi. Bileet, luontoretket, saunaillat ja kerhot takaavat sen, ettei elämä Viikissä ole koskaan tylsää. Muista sinäkin ajoittain sulkea tenttikirjasi ja tulla mukaan!
Biokeskus 3:n ensimmäisessä kerroksessa sijaitseva kerhohuone, Kertsi, on biologin toinen koti. Kertsillä voit hengailla luentojen välissä ja iltaisin, hörppiä kahvia tai teetä sekä ostaa pientä evästä. Luettavaksi voi kurssikirjan lisäksi valita vaikkapa ainejärjestön oman lehden, Symbiontin. Sohvalta löytyy aina juuri sinun kokoisesi kolo! Älä turhaan pelkää kertsillä oleilevia fossiileja (vuoden n opiskelijoita) – ne eivät pure, vaan ovat ihan kivoja.
Fuksin syksystä ei menoa puutu
Ennen orientaatioviikkoa tapaat tuutorisi ja muita fukseja Suomenlinnan preorientoivalla piknikillä. Syksyn mittaan tuttavuudet syvenevät lukuisissa tapahtumissa, kuten kertsibileissä ja fuksisitseillä. Kaunis ja rohkea tuutorisi johdattaa sinut kaikkiin syksyn tapahtumiin!
Alkusyksy huipentuu fuksiaisiin eli Biodiversiteettipeleihin, jossa sinut vihitään biologian opiskelijaksi. BD-pelin keksi hamassa menneisyydessä eräs symbiontti, ja aluksi sitä pelattiin
varsin kosteana lau tapelinä. Nykyään pelilauta on vaihtunut rastiradaksi, jota kierretään oman tuutoriryhmän kanssa upeissa asuis sa jännittäviä tehtäviä suorittaen. Pe lin jälkeen järjestetään mahtavat jatkot, joissa valitaan kunnioitetut vuoden gameetit.
Ahviksesta Shokkeloon
Biologeja kun ollaan, moneen tapahtumaan liit tyy luonto tavalla tai toisella. Vuoden kohokoh daksi on muodostunut keväinen Ahvenanmaan linturalli, jossa tarkoituksena on tunnistaa yhden vuorokauden aikana mahdollisimman monta lin tulajia. Kovimmat sissit lähtevät ralliin pyörällä, mukavuudenhaluiset köröttelevät ympäri Ahvista isukin autolla. Ralliin kannattaa osallistua vaikka et erottaisi varpusta variksesta, sillä hullumpaa ja hauskempaa tapahtumaa ei olekaan. Tiedät vasta kun koet rallin hurmoksen!

Rennot pöytäjuhlat eli sitsit ovat vahva osa biologien bileperinteitä. Sitseillä syödään herkullista ruokaa, lauletaan juomalauluja Symbioosin upeasta laulukirjasta ja juodaan enemmän tai vähemmän sivistyneesti ruokajuomia. Sitseille saa pukeutua parhaimpiinsa ja tutustua akateemisen maailman perinteisiin hyvässä seurassa! Syksyn alussa pääset heti sitsaamaan tuutorisi kanssa fuksisitseillä.
Yksi vuoden ikimuistoisimmista tapahtumista on ehdottomasti vapunpäivän Vappushokkelo.


Shokkelon järjestämisestä ovat vastuussa ensimmäisen vuoden opiskelijat, eli myös sinä! Shokkelo on loistava keino oppia tuntemaan paremmin oman vuosikurssin opiskelijoita sekä viettää ikimuistoinen vappu vaikkapa seepraksi pukeutuneena. Uurastuksen jälkeen työntekijöille on tarjolla jatkobileet ja pehmeät löylyt puusaunassa Kaisaniemen kasvitieteellisellä puutarhalla!
Symbiontti-lehti
Biologien voimin toimitettu lehti ilmestyy neljästi vuodessa sekä painettuna että netissä. Tyypillisesti jutut liittyvät enemmän tai vähemmän biologiaan tai järjestötoimintaan. Jutut voivat olla syvällisiä pohdintoja tai kieli poskessa kirjoiteltuja kevyempiä juttuja. Toimituksessa tekemistä riittää kaikille innokkaille kirjoittajille, piirtäjille ja taittajille, joten tervetuloa mukaan! Lehteen voit tutustua netissä täällä
Mukaan toimintaan pääsee helpoiten ilmaantumalla rohkeasti kertsille. Siellä voit ottaa rennosti muiden biologien kanssa ja jutustella luonnon ihanuudesta ja ihmeellisyydestä. Myös erilaiset tapahtumat ovat mainio tilaisuus tutustua muihin symbiontteihin. Järjestötoimintaan voit lähteä virallisemmin mukaan syyskokouksessa, jossa valitaan seuraavan vuoden hallitus ja virkailijat. Virkailijat ovat vastuussa esimerkiksi sitseille kokkaamisesta ja tapahtumien järjestämisestä. Yhdessä tekeminen on mitä mainioin tapa ystävystyä! Tule kokoukseen tsekkaamaan herkulliset tarjoilut, ja ehkä nappaat itsellesi pienen viran.
Nettisivut https://www.symbioosiry.fi/ Liity jäseneksi tästä linkistä
Facebook: Symbioosi ry Instagram: @symbioosiry
Symbioosin toimintaan (tai mihin tahansa) liittyviä kysymyksiä voi lähettää hallitukselle osoitteeseen symbioosi-h@helsinki.fi
������ Tervetuloa mukaan! ������



HelixryonHelsinginyliopistonbiokemian, mikrobiologiansekäsolu-jamolekyylibiologian ainejärjestö,jokavalvoojapyrkiiedistämään opiskelijoidensaetuaniinyliopistossakuin yhteiskunnassakin.Helixluomolekyylibiotieteilijöidenkeskuuteenyhteisöllisyyttäjärjestämällätapahtumia,excursioitajamuitatilaisuuksia,sekätarjoamallamahdollisuudenviettää aikaayhdessäkanssaopiskelijoidenseurassa.
Helixryperustettiinvuonna1969 edistämäänbiokemistienasemaaja oikeuksia,jasamatyöjatkuu edelleenyli50vuodenjälkeen. Opintovastaavammetoimivatlinkkinäyliopistonopetushenkilökunnanjaopiskelijoidenvälillätaistellen opetuksentasonylläpitämiseksi. Palautetta(niinrisujakuinruusujakin)jakehitysehdotuksiavoiesittääopintovastaavilleeteenpäinvälitettäväksijokohenkilökohtaisestitai nettisivuiltammelöytyvääpalautelomakettakäyttäen.
Moniahelikaaneja(Helixry:n jäseniä)löytyymyöstiedekuntaneuvostoistajakoulutusohjelmien johtoryhmistäsekäHelsinginyliopistonylioppilaskunnan(HYY) edustajistosta.Molekyylibiotieteilijöidenäänionsiishyvinedustettuna.





Yksiainejärjestöntärkeistätehtävistä onluodayhteisöllisyyttäjatuoda opiskelijaelämäänvastapainoaluennoillaistumiseenjamuistiinpanojen parissapuurtamiseen.Helixjärjestääkinrunsaastitapahtumiajokaiseen makuun.Bilepuoleltalöytyykertsibileitäjapöytäjuhliaelisitsejä, kulttuurinnälkäisilleontarjolla excursioitateattereihinjataidenäyttelyihin.Liikunnanosaltajärjestetääntutustumisexcursioitauusien lajienpariin.Helixjärjestäämyös työelämätapahtumiayhteistyössä ammattiliittoLoimunkanssa.Jaei pidäunohtaavalokuvauskerhoBiofilmiäjakiipeilykerhoSekvenssiä, joistakerrotaanenemmänHelixin osuudenjälkeen!


Helixin50vvuosijuhlat2019
HelixryjakaaBiosfääriry:nkanssa kerhohuoneen,tutumminKertsin, Biokeskus1:npohjakerroksessa huoneessa1014.Kertsinlöytää helpostikävelemälläalasensimmäisetportaatpääsisäänkäynnistä sisääntultaessa.Kertsionhelikaanienolohuone,johonvoitullaviettämäänaikaaluentojenvälissä(ja aikana).Omiaeväitäänvoilämmittää mikrossajakertsilläonmyösvälipalamyyntiä.Kirjahyllystälöytyy paljonalanoppikirjoja.Aikaansavoi kuluttaamyösPlaystationiatai lautapelejäpelaten,taiihanvaan sohvallaistuskellenilmapiiristä nauttien.


VapaaRadikaali
VapaaRadikaalieliVRonHelixry:n virallinenjärjestölehti.Helikaaneista koostuvatoimituskirjoittaa,kuvittaa jataittaaalustaloppuunlehden,joka ilmestyyneljäkertaavuodessa. Artikkelitkäsittelevätopiskeluunja opiskelijaelämäänliittyviäasioita, biotieteideneriaihepiirejäsekä ajankohtaisiaaiheitajaelämää yleisesti.Jokainenopiskelijavoi osallistualehdentekemiseenitselleensopivissamäärinjokokirjoittamisen,kuvittamisentaiideoimisen merkeissä.LehteävoilukeaKertsillä jakampuksellapaperiversionatai Issuu-nettipalvelussasähköisessä muodossa.VRtarjoaaopiskelijoille matalankynnyksenväyläntoteuttaa itseään,vaikuttaaasioihinjaosallistuajärjestötoimintaanvaikka omaltakotisohvalta.



Helixiinvoiliittyätäysinilmaiseksi verkkosivujemmekautta.Toiminta onkaikkienmuidenkinainejärjestöjentapaanvapaaehtoistenopiskelijoidenpyörittämää.Tarjollaon monenlaisiavirkoja,joihinvoi asettuaehdolleyhdistyksenvaalikokouksessaloppusyksyllä.Järjestötoimintaonerinomainentapaluoda uusiatuttavuuksiajasaadaarvokasta kokemustayhdistystoiminnasta (näyttäämyöshyvältäCV:ssä!).
Arvostammesinuakuitenkinjuuri sellaisenakuinolet:voitvainnauttia yhdistyksentarjoamistapalveluista jaaktiviteeteistataivoitantaaoman panoksesijärjestöntoimintaanja tulevaisuuteen!

Varsinaiseksijäseneksivoiliittyä kukatahansaHelsinginyliopistossa alempaataiylempääkorkeakoulua suorittavaopiskelija,jonkaopintoihinkuuluuvaikkavainyksikinkurssi biotieteitä.Liittymislinkkilöytyy nettisivuiltamme helix-ry.fi:

SeuraaHelixry:tämyössomessa: Facebook: Helixry Instagram: helix_ry
VirallinenTelegram: Rotankolo


Svenska Naturvetarklubben rf
Svunken, svenskit, betarna, naturvetarna… kärt barn har många namn. Svenska Naturvetarklubben är ämnesföreningen för svenskspråkiga studerande på bio- och miljövetenskapliga fakulteten vid Helsingfors universitet. SvNK grundades 1920 och är en av de äldsta ämnesföreningarna vid HU.
Var du hittar oss
SvNK har en klubblokal, ”Klubben”, som vi delar med Spektrum r.f. (fysiker, kemister, matematiker och datavetare) på Kyrkogatan 10 i Kronohagen. På den legendariska Klubben ordnas största delen av SvNK:s fester och andra evenemang. Dessutom delar vi på ”Kertsin”, dvs. klubbrummet i första våningen i Biocenter 3, med Symbioosi och MYY. I detta rum har vi ett litet bibliotek, där man bl.a. kan hitta gamla men eventuellt användbara upplagor av vissa tent- och artkännedomsböcker. I Kertsin kan man vila sig, och kaffekokaren står nästan alltid varm. Kertsin är perfekt placerad med tanke på första årets föreläsningar. Välkommen att pigga upp dig mellan föreläsningarna och bekanta dig med andra biologer än dina kurskompisar!
Svunken ordnar en hel del evenemang av olika karaktär för sina medlemmar. Årets tre fågelexkursioner (uggle-, vårfågel- och höstfågelexkursion) är en viktig del av SvNK:s program, och för dem får man även studiepoäng. Förutom dessa traditionella exkursioner ordnas även andra mindre utflykter.
En annan viktig del av Svunkens aktivitet är ordnandet av fester. För gulnäbbarnas del (dvs. första årets studerande) börjar året med gulnäbbsintagning på hösten, varefter de introduceras till den ädla konsten att sitsa. Sitser ordnas regelbundet under året, ofta med något tema. En av årets höjdpunkter är julfesten, där såväl yngre som äldre studerande festar till de tidiga morgontimmarna. En gång i månaden ordnar Svunken programkvällar såsom spelkvällar och filmkvällar. Dessutom ordnas sportevenemang med jämna mellanrum.
SvNK deltar också i evenemang ordnade av andra studentföreningar, bl.a. har vi med stor framgång deltagit i ölorienteringen Ylonz, och gulnäbbarna brukar vara välrepresenterade på Fest 1, en fest som är avsedd för första årets studerande och ordnas av Teknologföreningen. Med våra Klubbenkompisar, spektrumiterna, har vi en hel del samarbete. Tillsammans med Spektrum firas åtminstone kräftskiva, vändag och fastlagstisdag, ofta även julfest och valborg. Till Symbioosi och Helix har vi också nära och goda kontakter, vi brukar bjuda in dessa föreningar till gemensamma sitser och vi är också välkomna på deras evenemang. På många fester används studentoveraller, s.k. halare. SvNK:s mörkblå halare kan ni få redan under hösten om ni är riktigt aktiva. Om ni får ihop tillräckligt med sponsorer för halarna kostar de inte er något.
Hur du kommer med Svunken välkomnar dig varmt till alla tänkbara evenemang. Om du ens är ett dugg intresserad av föreningens verksamhet i allmänhet, kom då också med på något av våra månadsmöten.
Kom ihåg att följa med e-postlistan! Via den får du förutom information om SvNK:s program också information om ändringar i undervisningen, nya kurser och sommarjobb. Din tutor hjälper dig komma med på listan. Glöm inte heller att kolla hemsidan https://blogs.helsinki. fi/svenskanaturvetarklubben/ Där hittar du bl.a. information om föreningen, evenemangskalendern och bloggen som skrivs av våra medlemmar om smått och gott som hör studie- och arbetslivet till.
Är det något du undrar över med studierna? SvNK är också till för att hjälpa dig och för att bevaka svenskspråkiga studerandes intresse. Tveka inte att kontakta SvNK även gällande studieärenden.
Styrelsen når du enklast per e-post till svnk-s@helsinki.fi.
Vill du träffa trevliga människor och få ut mer av din studietid är det en superb idé att bli medlem och aktiv (åtminstone på sitser) i SvNK. Vi ses i höst! #svnk4life
Mikä MYY?
MYY on kahdessa tiedekunnassa toimiva ainejärjestö. Ympäristöasiat ovat lähellä sydäntämme. Haluamme muuttaa maailmaa ja löytää ratkaisuja aikamme polttaviin ongelmiin, kuten ilmastonmuutokseen ja biodiversiteetin hupenemiseen. Toimimme ympäristöhengessä, joten esimerkiksi sitseillämme tarjotaan vegaanista safkaa, joka on vertaansa vailla. Vaikka kaiken takana on vanha kunnon hippiaate, ovat myyläiset ihan täysjärkistä ja mukavaa porukkaa.
Fuksivuonna on mahdollisuus löytää se oma paikka yliopistossa, ja vaikka siihen saattaa mennä tovi, omaa juttuaan kannattaa hieman haeskella. Toimintaamme kannattaakin tulla rohkeasti tutustumaan pääaineesta riippumatta!
Mitä MYY tekee?
Vastaus on, että pitkälti ihan samoja juttuja kun muutkin järjestöt, mutta omalla

twistillään. Järjestämme bileitä, ulkomaanexcuja ja meillä on useita kerhoja. Kasvisruokakerho, kalakerho Vimmat ja huispausjoukkue MyyRyhmyt tarjoavat monenlaista tekemistä. Vuoden kohokohtia ovat ehdottomasti pikkujouluviikonloppu Karkkilassa ja Vapun Kotiviinikilpailu. Perimätiedon mukaan kotiviinikisoissa paistaa aina aurinko, joten kotiviinikisoilla on hyvä aloittaa vappuaaton juhlinta!
Pidämme jäsenistömme ääntä kuuluvissa myös yliopiston suuntaan ja teemme vahvaa työelämätoimintaa. Myyssä tehdään paljon muutakin kuin vain niitä ympäristöjuttuja, ja meidän lämminhenkisestä porukasta voi hyvinkin löytyä oma ekologinen lokero just sulle. Jos esimerkiksi toimihenkilönä toimiminen tai ainejärjestöhommat kiinnostavat lähde rohkeasti mukaan! Meidät löytää Biokeskus 3:n kertsiltä ja tunnistaa tummanvihreistä haalareista.
Facebook: MYY ry Instagram: myy.ry

Opiskelijantukijaäänenkannattaja
Bio-jaympäristötieteellisentiedekunnantiedekuntajärjestö Biosfääriryonvuonna2010perustettuBYTDK:nopiskelijoidenlämminhenkinenäänenkannattaja,jokavalvoo jokaisenopiskelijansaetuaniinjuhlissakuinjokapäiväisessä opiskelussakin.BiosfäärinjäseniäovatainejärjestötHelixry, MYYry,SvNKrfjaSymbioosiry,joidenkauttasinäkin kuulutBiosfääriin!
MitenBiosfäärinäkyyarjessasi?
Biosfääriinpääsettutustumaanheti opintojesialussa.Syksynalussa Biosfäärijärjestääpaljonerilaisia tapahtumia,joissapääsettutustumaanuusiinopiskelijatovereihisi. SyksynavaaPre-orientoivapäivä Suomenlinnassaennenorientoivaa viikkoa,jolloinjärjestetäänmonenmoistahauskaalautapeli-illasta Fuksi-bileisiin.

VuodenkuluessaBiosfäärijärjestää paljontiedekuntarajatylittäviä tapahtumia,kutenyhteissitsejäja suuriabileitämuidentiedekuntajärjestöjenkanssa.Jottapysyt perilläsiitä,mitäBiosfäärissätapahtuu,kannattaakäydätykkäämässä meistäFacebookissajaseurata Instagramissa!Tiedotuskanaviimme kuuluvatnäidenlisäksinettisivut (www.biosfaari.org),ainejärjestöjen sähköpostilistat,sekäkoko tiedekunnanjärjestöjenTelegramtiedotuskanava.Näidenkauttapysyt ajantasallamuutoksistatiedekunnassamme,opiskelijaedustajien haustasekätulevistatapahtumista. VoitliittyäTelegramintiedotuskanavalleallaolevanQR-koodin kautta:

MitensinähyödytBiosfääristä?
Biosfäärinavullapysytajantasalla siitä,mitätiedekunnassammetapahtuu.Nettisivuiltammelöydättapahtumakalenterin,jostalöydätBiosfäärinsekäjäsenjärjestöjemmetulevattapahtumat.Nettisivuillammeon myöspaljontietoamuunmuassa opiskelijoidenedunvalvonnasta. Nettisivuiltalöydätmyöspalautelomakkeen,jollavoitantaapalautettatoiminnastamme.
Biletapahtumienlisäksijärjestämme työelämäänliittyviätapahtumia, kutenCV-työpajojayhdessäalamme ammattiliittoLoimunkanssa.Täältä saatsuoriavinkkejätyönhakuunja tulevaanuraanliittyentyöelämän osaajilta!
TärkeinosaBiosfäärintoimintaaon opiskelijoidenedunvalvonta.Puutummeopiskelijoidenkohtaamiin epäkohtiintiedekuntammetoiminnassa,sekäkeräämmepalautetta kursseista.Viemmepalautettamyös eteenpäinopettajille,jotenkannattaa käydäarvioimassakäymiäsi kursseja!Voitollamyössuoraan yhteydessähallitukseentai opintovastaaviin.
Mitenpääsenmukaan toimintaan?
Osallistumallatapahtumiin!Jos haluatmukaanjärjestämään tapahtumia,valvomaanopiskelijoidenetuja,järjestämäänKV(kansainvälisiä)-tapahtumia,niinoleyhteydessähallitukseen.Hallituksen jäsentenesittelytlöydätnettisivuilta, facebookistajainstagramista.Jos jokintiettypestikiinnostaa,käy nykäisemässäkyseisestäosaalueestavastaavaahallituksen jäsentähihastajakysylisätietoja! Voitlaittaamyössähköpostia hallitukselletaipuheenjohtajalle. Hallitusviratjaetaanvaalikokouksessamarras-joulukuunvaihteessa.Jostoimintammekiinnostaa, lähderohkeastimukaan!
JossinullaonkysyttävääBiosfäärin toimintaan,tapahtumiintaiihan mihintahansaliittyen,voitainaolla meihinyhteydessä!Fuksi-ja tuutorivastaavaauttaamielellään kaikissaopintojenalkuunliittyvissä asioissa.
Yhteystiedot
Yhteystiedot:
Puheenjohtaja Albert Lenkiewicz puheenjohtaja@biosfaari.org
PuheenjohtajaOonaHartikainen: puheenjohtaja(at)biosfaari.org
Fuksi- ja tuutorivastaava Sanna Tervo futuvastaava@biosfaari.org
Fuksi-jatuutorivastaavaSanna Tervo:futuvastaava(at)biosfaari.org
Hallitus hallitus@biosfaari.org
Hallitus:hallitus(at)biosfaari.org MikrobiologianjamikrobibiotekniikanmaisteriohjelmatoimiiMaatalous-metsätieteellisen tiedekunnan(MMTDK)alaisuudessa,minkä takiaHelixrykuuluukinkahteentiedekuntaan. Tämätarkoittaa,ettäHelixry:lläonkaksi tiedekuntajärjestöäkattojärjestöinään:BYTDK:n BiosfääriryjaMMTDK:nMMYLry (Maatalous-metsäylioppilaidenliitto).
VoitlukealisääMMYLry:stäesimerkiksiheidän omastafuksioppaastaan,jokalöytyyyhdistyksen nettisivuilta:mmyl.fi



Kiinnostaakokiipeily,muttavarmistuskaveripuuttuu? Haluaisitkolähteäulkokiville,muttaetomistapädiä?Helixin uusikiipeilykerhoSekvenssiauttaamolemmissatilanteissa!
Sekvenssiperustettiinhelmikuussa 2022Helixinliikuntavastaavien aloitteesta,tavoitteenatuodayhteen kaikkikiipeilevätjakiipeilystä kiinnostuneethelikaanit,silläporukallakaikkionainahauskempaa!
Sekvenssissäboulderoidaanja köysikiipeillään,jotenkavereita seinällelöytyyvarmastiaina.
Boulderoinnissakiivetäänyleensä alle5metrisiäseiniä,kiviätai kallioitailmanvarmistusvälineitä, kuntaasköysikiipeilyssäkiivetään korkeampiaseiniäjakallioitaniin, ettäkiipeilijäonkiinniköydessäja varmistajavarmistaavarmistuslaitteenavullaalhaalla.Yläköysikiipeilyssäköysikulkeekiipeilijän valjaisiinyläkautta,jamahdollinen putoaminentapahtuukäytännössä melkeinkireäänköyteen. Alaköysikiipeilyssäköysikulkee kiipeilijänmukanaalakauttaja
kiipeilijäkiinnittääköyttä välivarmistuksiin(jatkoihin)reittiäedetessään, jolloinpudotustausein tuleemuutamametri edellisenjatkonsijainnista riippuen.Ylä-jaalaköysittelyynsisätiloissavaaditaanSuomessavarmistuskortti,jonkavoi suorittaakiipeilyhallilla. Köysikiipeilyäonkuitenkinmyösmahdollista testataitsevarmistavien laitteidenavullatai varmistukortinomistavan kaverinkanssa.Boulderoinnissaeivaaditaminkäänlaisiaennakkotietoja tai-taitoja,riittääettä hallilleottaamukaan joustavatvaatteet.


TervetulleitamukaanSekvenssiin ovatkaikkiaiemmastakokemuksesta riippumatta,eisiishuoltamikäli haluaisittullakokeilemaanlajiaihan ensimmäistäkertaa-kiipeilijätovat hyviätsemppaamaanoligreidimikä hyvänsä.SekvenssitoimiiFacebookjaWhatsApp-ryhmienkautta,joten toimintaanmukaanlähteminenei vaadipaljoa. Skannaasiisoheinen QR-koodi taietsiFacebookista ryhmänimeltä“Helixry:n kiipeilykerhoSekvenssi”jaliity mukaan!





Onnittelut sinulle Suomen parhaimpaan yliopistoon pääsemisestä. Olkoon fuksivuotesi ikimuistoinen!
Tulet huomaamaan, että laulaminen värittää opiskelijaelämää – se kuuluu akateemisten pöytäjuhlien perinteeseen, ja sitä harjoitetaan myös epävirallisemmissa yhteyksissä, kuten mielenosoituksissa ja saunan lauteilla. Kun sitseillä laulaminen ei enää riitä, löytävät opiskelijat itsensä myös akateemisista kuoroista. Mikäli sinua kiinnostaa kuorolaulaminen tai jos laulukärpänen puree ensimmäisillä fuksisitseillä, olet lämpimästi tervetullut liittymään Symbioosin kuoroon!
Symbioosin kuoro on perustettu 1994. Alun perin kuoro toimi nimellä ”Symbioosin lauluyhtye”, ja ohjelmistoon kuului lähinnä juomalauluja. Myöhemmin nimi vakiintui
Symbioosin kuoroksi, ja nykyään ohjelmistoomme kuuluu laidasta laitaan niin kuoroklassikoita kuin kevyempää popmusiikkia. Laulukielinä ovat pääsääntöisesti suomi, englanti ja ruotsi, mutta toisinaan myös saksa, espanja ja munkkilatina.
Vaikka kyseessä on nimenomaan Symbioosin kuoro, löytyy joukoistamme saapasjalka- ja valkotakki-
biologien lisäksi myös muun muassa ympäristöekologeja, sosiologeja, psykologeja ja humanisteja. Ääni- ja oppialojen rajat ylittävä kuoromme koostuu akateemisesti kaikenikäisistä laulajista fukseista ännännen vuoden opiskelijoihin ja alumneihin saakka.
Treenaamme noin 20 hengen voimin kuoronjohtajan johdolla kerran viikossa Kaisaniemen kasvitieteellisen puutarhan kasvihuoneilla. Järjestämme vuosittain joulu- ja kevätkonsertin, minkä lisäksi esiinnymme myös yksityistilaisuuksissa. Ajoittainen esiintyminen tuo pientä jännitystä elämään ja on vieläpä hurjan hauskaa!
Pidämme uusien laulajien illat uuden lukuvuoden alussa syyskuussa kahtena maanantaina Kaisaniemen kasvitieteellisen puutarhan kasvihuoneilla. Tervetuloa tutustumaan! Tiedotamme avoimista harjoituksista tarkemmin sähköpostilistoilla, ja lisää tietoa ajankohtaisista tapahtumista löydät somesta:
Facebook: Symbioosin kuoro
Instagram: @symbioosinkuoro


Löytyykörohkeuttaheittäyttyä,jaluonnemestarin?
SisuInternationalSportsUnitedry, eliSISUry,onViikinkampuksen opiskelijoistamuodostuvapoikkitieteellinenjärjestö,jonkatavoitteenaonedistääviikkiläistä yhteishenkeäjaurheilukulttuuria monipuolistentapahtumienkautta. SISUryperustettiinkeväällä2021 MMYLry:njamaatalousmetsätieteellisentiedekunnan70vuotisenperinteen-PM-kisojenpohjilta.PM-kisoissakampuksen opiskelijoistakoottujoukkuekisaa muitaPohjoismaisiayliopistoja vastaankuusipäiväisessäspektaakkelissa.SISUntavoitteenaontuoda kisoissavallitsevamahtavayhteisöllisyysentistäkinvahvemmaksi osaksiviikkiläistenopiskelijoiden arkea!
TavoitteentoteuttamiseksiSISU järjestääviikkiläisillejosjonkimoisia urheiluhäppeninkejä,kaikkealajikokeiluistajakesäriehastagrundi-
bileisiinjaainejärjestöjenvälisiin derbyihin!Kuitenkin,nytsyksyllä 2023päähuomioonauttamatta vuodenpäätapahtumassa,Tanskan KööpenhaminassakisattavissaPMkisoissa.Suomilähteekisoihinpuolustamaanvuonna2022kotikisoissa voitettuakisakultaa.18.-25.syyskuutavietettävätkisatmuodostuvat yltäkylläisestäkattauksestahillitöntä jamukaansatempaavaameininkiä päivisinkisattavineurheilulajeineen sekäiltaisinpidettävinejuhlineen. Myösfukseilleonvarattutänne muutamapaikka,jotenkannattaa liittyävälittömästimeidäntiedotuskanavalle!
Heräsiköuteliaisuus?Otameidän Instagramhaltuuntägillä @viikinkarhuofficial,jalöydätkaikkioleellisetlinkit(kutenpääsytiedotuskanavalle)osoitteestalinktr.ee/ viikinkarhuofficial
Moi kaikki ja suuret onnittelut koulupaikasta! Me ollaan Emily, Karoliina ja Ilona ja toimitaan yhessä tuutorikolmikkona. Oltiin samassa tuutoriryhmässä ja löydettiin toisemme heti preorientaatiossa :D
Moii! Mä oon Emily, oon tossa kuvassa oikealla. Mä oon suuntautunu mikrobilsaan ja musta tulee myös bilsan ja mantsan ope. :) Tykkään bilsasta ku se on niin monipuolista ja mielenkiintosta. Lempijuttuja ekana vuonna on ollu ainaki labrat ja uudet tyypit! Vapaa-ajalla tykkään urheilla, olla luonnossa, kuunnella podcasteja ja viettää aikaa mun koiranpennun kaa. <3
Moi, mä oon Karoliina (kuvassa vasemmalla)! Aloitan nyt syksyllä mun toisen vuoden bilsalla ja aion suuntautua ekologiaan ja evoluutioon. Sen lisäksi mua kiinnostaisi tehdä akvaattisten tieteiden ja mikrobilsan opintoja. Meillä asuu kotona kaksi kissaa ja harrastan tanssia. Luonnossa liikkuminen on mun mielestä mukavaa ja tykkään syksyisin sienestää. Ekalta vuodelta tykkäsin erityisesti BD-peleistä ja kenttiksestä :3
Hellou mä oon Ilona ja löydyn kuvasta keskimmäisenä. Mua kiinnostaa bilsassa vähän kaikki, mut solubilsalla ja perinnöllisyydellä on erityinen paikka mun sydämessä, joten oon suuntautumassa genetiikkaan. Koulun ulkopuolella käyn vähän liian paljon keikoilla, luen kirjoja ja kattelen kauhuelokuvia. Omasta fuksivuodesta jäi parhaiten mieleen BD-pelit, joulurisse, labrat ja kesän kenttäkurssi.
Ootetaan innolla teidän tapaamista ja tehdään parhaamme, jotta teillä olis mahtava fuksivuosi!

Helou evribadi ja onnittelut opiskelupaikasta uusille fukseille! Me ollaan Ella ja Helmi (ei ne tubettajat, älkää nyt liikaa innostuko ;)), ja ollaan molemmat toisen vuoden opiskelijoita bilsalla. Odotetaan jo innolla, että päästään tapaamaan meidän uusi tuutorryhmä ja saadaan opastaa teidät ikimuistoisen fuksivuoden alkuun. Meidän fuksivuodessa parasta oli ehdottomasti BD-pelit, Kilpisjärven excu, Lammin kenttäkurssi ja tietysti kaikki sitsit!
Hellurei, mie oon siis Helmi ja kuvassa nökötän vasemmalla puolella! Oon kotoisin Joensuusta, Pohjois-Karjalasta, mutta viime syksynä muutin tänne Helsinkiin opintojen perässä. Mie suuntaudun genetiikkaan, koska perinnöllisyys ja solujen toiminta on aina kiehtonut minuu tosi paljon. Opiskelen lisäksi aineenopettajalinjalla ja aattelin valita kemian miun toiseksi opetettavaksi aineeksi, koska ajattelin siitä olevan hyötyä myös tuossa genetiikassa ja on se ihan kivaakin sillon kun sitä ymmärtää :’). Vapaa-ajalla tykkään lenkkeillä, käydä salilla, leipoa ja tehdä käsitöitä, etenkin neulominen on miulle tosi rakasta puuhaa. Kesäisin parasta on vaellusreissut ja tietysti sienestäminen!
Moii! Mä oon Ella ja kuvassa istuskelen tossa oikealla! Oon asunu tähänastisen elämän aina pk-seudulla. Bilsalla mua kiinnostaa paljon genetiikka, johon oonkin (näillä näkymin:D) suuntautumassa, mut suoritan kursseja myös mikrobiologian puolelta. Toisaalta myös aivojen toiminta ja ylipäätään neurotiede kiehtoo, joten eivätpä ainakaan vaihtoehdot lopu kesken. Vapaa-aika kuluu mulla ajan ja motivaation salliessa aina taide- ja musiikkijuttujen parissa! Tykkään piirtää, maalata, soittaa pianoo ja kitaraa, tehä vaatteita ja olla mukana kaikenlaisissa leffaproggiksissa.

Hei!! Onnittelut opiskelupaikasta bilsalla!!1! Me ollaan Arttu ja Alma ja ollaan toisen vuoden bilsalaisia. Molemmat suuntaudutaan genetiikkaan, jossa kumpaakin kiinnostaa erityisesti geenitekniikka ja siirtogeeniset organismit. Tuutoriparina me halutaan mahdollistaa teille fukseille mitä mainioin startti yliopistopolulle.
Alma: Olen alkujaan kotoisin Järvenpäästä, josta muutin fuksivuoden alussa lähelle kampusta Pihlajistoon kämppiksen ja kolmen marsukaverin kanssa. Opintojen ohessa käyn kuntosalilla sekä luen tai kuuntelen kirjoja ja podcasteja. Spontaanit matkustelureissut on mun mieleen, joista parhaita on tietty kaikki luontokohteet ja vaellukset. Myös kuvataiteet on suuri intohimoni ja olenkin tässä noin vuoden ajan harjoitellut myös tatuoimista! Bilsassa mua kiehtoo paljon genetiikan lisäksi myös mm. fysiologia ja virologia ja ajattelin sisällyttää niitä opintoihini. Lempparijuttuja fuksivuonna on ollut labrat ja kaikennäköiset opiskelijameiningit!
Arttu: Asun Maunulassa kahden rotan (Rattus norvegicus) kanssa. Vietän mielelläni aikaa ulkona ja pidän erityisesti saaristosta. Tykkään kasvattaa hyötykasveja parvekkeella ja yritän myös pitää vaihtelevalla menestyksellä huonekasvejani hengissä. Bilsassa genetiikan lisäksi kiehtoo yksilönkehitys ja evoluutio sekä luonnon monimuotoisuuteen liittyvät jutut. Ekana vuonna tykkäsin labratyöskentelyn lisäksi myös fysiologian kursseista ja yllättäen oli ihan hauska oppia myös lajituntemusta. Olen tykännyt kaikista opiskelijatapahtumista ja fuksivuonna parasta oli mm. BD-pelit ja happobileet.

Moi! Oon Onni ja toisen vuoden bilsalainen ja suoritan kaksikielistä tutkintoa, siis tuttavallisemmin tvexiä. Tvex-tuutorina pyörin missä milloinkin ja multa voi kysyä etenkin, jos mietityttää jokin tuohon kaksikieliseen tutkintoon liittyen, ja toki ihan muissakin asioissa. Matalalla kynnyksellä kannattaa tulla kyselemään jos jokin askarruttaa.
Oon kotoisin Raaseporista ja pari vuotta nyt Helsingissä asustellut. Bilsalla suuntaudun fysiologiaan ja neurotieteeseen ja siinä etenkin kehitysbiologia kiinnostaa. Lisäksi mm. globaali kestävyys ja meribiologia kiinnostelevat. Kaksikielistä tutkintoa lähdin suorittamaan ihan halusta tutustua uusiin ihmisiin ja parantaa omaa ruotsin kielen taitoa. Tvexiä voi ajatella myös tavallaan ruotsinkielisenä fuksivuotena, 60 opintopistettä kun on ruotsiksi tarkoitus tehdä.
Vapaa-ajalla tykkään liikkua ja kuunnella musiikkia sekä kuluttaa Duolingoa. Opiskelijatapahtumista erityisesti oon tykännyt vaihtaritapahtumista, Kilpisjärvi-excursio ja kenttäkurssi on jääny myös mieleen. Luonto on lähellä sydäntä ja mut löytääkin hyvin todennäköisesti Symbioosin sekä Myyn linturetkiltä.
Onnittelut pääsystä bilsalle ja tervetuloa!

Heipä hei! Ootte päässeet HY:n parhaalle alalle, onnittelut! Me ollaan Ilja ja Lassi ja alotellaan tokaa vuotta kyseisellä hienolla alalla! Ilja erikoistuu tai sit ei ja Lassista tulee (toivottavasti) ekologi. Tuutoreina haluamme varmistaa, että teidän ensimmäisestä vuodestanne (tai vähintääkin orientaatioviikosta) tulee yhtä hauska kuin meidän fuksivuodesta.
Lassi: Olen syntyjäänkin hesalainen ja asun Kalliossa, mutta alhaalla olevassa kuvassa olen epätyypillisesti oikealla. Asun siellä tyttöystäväni Millan ja leopardigekkoni Pablon (Escobar?) kanssa. Suojelubiologia ja lajikonservaatio kiinnostaa, joten erikoistun ekologiaan. Vapaa-aikani käytän usein musiikin ja videopelien parissa tai kun siihen mahdollisuus on niin luonnossa. Fuksivuoden kohokohtia oli ehdottomasti Happobileiden järjestäminen keväällä ja kesän kenttis oli mahtava! Vanhojen päivää odotellessa ;)
Ps. Olen toinen tämän vuoden fuksi- ja tuutorivastaavista, joten mulle voi millon vaan laittaa viestiä tai tulla vetää hihasta, jos jokin asia askarruttaa :)
Ilja: Muutin pois Chicagosta (Lahest siis) vuosi sitten opiskelemaan tänne Helsinkiin. Täällä asun Puksussa toistaiseksi solussa. Voitte haluttaessa kysyä minulta soluelämästä lisää. Minua kiinnostaa erityisesti eläinten rakenne ja toiminta sekä niiden yhteys niiden ympäristöön, minkä takia luultavammin erikoistun fysiologiaan. Mutta onhan tässä vielä aikaa miettiä. Vapaa-ajalla käyn kävelyillä kaupungissa tai luonnossa, pelaan videopelejä ja rakennan palapelejä. Fuksivuosi oli täynnä hienoja ja mielenkiintoisia asioita, mutta jos niistä pitää erottaa parhaimpia niin lista olisi seuraava: Luonnontieteilijoiden jouluristeily, Vappushokkelo ja kenttis.

Moikka kaikki ja onnea bilsalle pääsystä!! Me ollaan Noona ja Selma (labraparit ensimmäisestä rotanleikkelydemosta asti) ja me toimitaan yhdessä teidän tuutori-duona. Me odotetaan jo innolla orientaatioviikkoa, sekä teidän fuksien tapaamista!
Moi! Mä oon Noona (kuvassa vasemmanpuoleinen merirosvo) ja oon suuntautumassa genetiikkaan. Fuksivuonna mun lemppareita oli etenkin labrat ja fysiologian kurssit. Vapaa-ajalla tykkään viettää aikaa kavereiden kaa, lukea ja tietenkin käydä erilaisissa opiskelijatapahtumissa (lemppareita mm. BD-pelit ja sitsit). Ootan innolla teihin tutustumista!
Moikka! Oon Selma eli toi kuvan oikeanpuoleinen merirosvo. Biologiassa mua kiinnostaa vähän kaikki, joten en oo osannut valita vielä mitään tiettyä suuntautumista, mutta toivottavasti orientaatioviikolla osaan jo sanoa, mihin suuntaudun. Opintojen ohella hoitelen mun huonekasveista koostuvaa kotiviidakkoa ja teen vaellusreissuja ulkomaille silloin kun koulu sekä työt sallii! Fuksivuonna mun mielestä parasta orientaatioviikon lisäksi oli ehdottomasti BD-pelit, kenttis, Vappushokkelo sekä sitsit. Kuulun myös tän vuoden Symbioosin hallitukseen, joten jos ainejärjestön hommat kiinnostaa niin tulkaa ihmeessä nykäisemään hihasta (tai koukusta)!

Heips ja onnittelut opiskelupaikasta! Me ollaan Tia (kuvassa vasemmalla) ja Sinna (kuvassa oikealla) ja alotellaan toista vuotta bilsalla. Tavattiin ensimmäisen kerran pre-orientoivana päivänä ja ollaankin oltu erottamaton kaksikko siitä asti. Odotetaan innolla orientaatioviikkoa ja ennen kaikkea teidän tapaamista!
Tia: Oon kotoisin Leppävaarasta ja oon asustellut ympäri Helsinkiä viimeiset neljä vuotta, tällä hetkellä majailen Rastilassa. Vapaa-ajalla tykkään ulkoilla, käydä salilla ja museoissa sekä nähdä kavereita. Ravaan myös paljon Tampereella (R-juna <3). Bilsalla parasta on ollut opintojen monipuolisuus, ja ekan vuoden aikana pääseekin tekemään kaikkee siistiä! Tällä hetkellä mua kiinnostaa eniten mikrobiologia, mutta fysiologia ja neurotiede houkuttelee kans. Katellaan sit syssymmällä, et mitä mieltä oon sillon :D Lempparijuttuja fuksivuonna oli erilaiset opiskelijatapahtumat (erityisesti sitsit ja approt), Tvärminnen fuksivierailu sekä kenttäkurssi. Nähdään syksyllä!
Sinna: Kunnon pk-seutulaisen elkein jäin minäkin tuttuun ja turvalliseen Helsinkiin pänttäämään tätä bilsaa. Nuuksion metsät on kuitenki lähellä sydäntä ja tarviinki säännöllisin väliajoin vähintään jonkinasteista metsäilyä selvitäkseni kaupunkiarjesta. Bilsalla vetää puoleensa näillä näkymin neurotiede ja fysiologia, mutta vähän katse suuntaa jo tulevaisuuteen, että mitä tän jälkeen. Opintoihin antasin sellasen vinkin, että ottakaa kaikki irti ainaki jokasesta ilmasesta tapahtumasta ja mahiksesta, mut käykää luentomatskut läpi huolella ni saatte parhaan fuksivuoden :D Hurlumhei ja tie kouluun vei!
Ps: Oltiin molemmat tanssijoita viimeisimmässä Viikki-speksin produktiossa (Marrasmäki 13), ja suositellaankin lämpimästi speksiin hakemista! Kerrotaan teille mielellämme lisää <3

Moi! Ollaan Iida, Ellen ja Laura ja alotetaan nyt toinen vuosi bilsalla. Meistä Iitsu ja Eltsu suuntautuu genetiikkaan ja Lasku luultavasti ekologiaan. Kimble (Laura) on myös yksi meidän tän vuoden fuksi- ja tuutorivastaavista eli rohkeesti ottamaan yhteyttä jos joku asia mietityttää!
Muutama hauska fakta meistä:
- Lapukka murs jalkansa symbioosin pikkujouluissa I’m still standingin tahtiin
- Iidsku keitteli soluasuntonsa keittiössä kyyhkysen rintalastaa eläindemojen jälkeen (fuksisyksyn paras kurssi!!)
- Ja Elsu the academic weapon oli kenkänokkaakin harvinaisempi havainto luentosaleissa talven pimeinä kuukausina.
Ootetaan innolla että päästään tutustumaan teihin kaikkiin ja viettämään teiän kanssa parasta fuksivuotta!
Terveisin your favourite academic victims, Kahvi(vas.), Elpukka(kesk.) ja Lasku(oik.) ← huom ei poliittista ;)

Moikka ja onnittelut opiskelupaikasta sekä aivan loistavasta alavalinnasta! Mun nimi on Nova ja aloittelen nyt toista vuotta biologian opintoja fysiologian ja neurotieteen parissa. Toivottavasti saadaan teille järjestettyä ihan huikee orientaatioviikko ja eka syksy yliopistossa!
Muutama fakta musta:
- Oon kotosin Savon pääkaupungista eli Kuopiosta :)
- Tykkäsin ekana vuonna eniten labroista ja fysiologian kursseista
- Fuksivuoden kohokohtia mulle oli ehottomasti speksi ja Vappushokkelo
- Mun lemppari julkinen Helsingissä on metro jostain syystä
Orientaatiossa nähdään!

Moi, onnittelut opiskelupaikasta ja tervetuloa Viikkiin! <3 Me ollaan Vilma, Salme ja Katariina ja ollaan tokaa vuotta bilsalla. Meistä Katariina erikoistuu mikrobilsaan ja Vilma ja Salme kasvitieteeseen (todennäköisesti). Toivottavasti nähdään orientaatioviikolla!
Vilma: Hauska fakta: oon syntyperäinen viikkiläinen. Suurimman osan elämästäni oon kuitenkin asunut Espoossa ja nykyään asun Pitäjänmäellä kuudentoista kämppikseni kera (1 ihminen, 2 kissaa ja 13 akvaariokalaa). Kuvassa tosin on vanhempieni kissa. :) Vapaa-ajalla virkkaan, taiteilen, pelaan videopelejä ja liikun luonnossa. Bilsassa itseäni kiinnostaa etenkin ympäristöasiat, mutta myös solutason jutut ovat todella mielenkiintoisia. Fuksivuoden kohokohtia olivat Kilppari-excu ja Ahvis!
Salme: Oon kotosin täältä Helsingistä ja asunut koko elämäni Itä-Pasilassa. Oon suuntautumassa kasvitieteeseen, koska kasvit on super kiehtovia ja ihmeellisiä. Nyt syksyllä suuntaan kumminkin Kumpulaan opiskelemaan maantiedettä, sillä sain oikeuden pedagogisiin opintoihin ja maantiede on mun toinen opetettava aine. Tykkään pyöräillä (hyvällä säällä) ja yritän kulkea aina kun mahdollista pyörällä paikasta toiseen. Oon harrastanut muodostelmaluistelua melkein koko elämäni ja käyn edelleenki kerran viikossa luistelemassa. Meillä on kotona pieni ihana oma koiralauma. Mun fuksivuoden lempparijuttuja oli mm. Ahvis ja kenttis!
Katariina: Oon alun perin kotoisin Keravalta, mutta pääsin onneksi pakenemaan Helsinkiin ja oon asunut täällä nyt muutaman vuoden. Käyn kuitenkin aina välillä kotikotona moikkaamassa meidän kahta kissaa ja oon 100% kissaihminen. Suuntaudun mikrobilsaan, vaikkakin kaikissa bilsan aihealueissa on jotain kiinnostavaa. Oon myös yksi meidän tiedekuntajärjestö Biosfäärin tapahtumavastaavista, joten jos tulee mieleen jotain mehukkaita tapahtumaideoita niin saa tulla nykäisemään hihasta! Vapaa-ajalla tykkään käydä taidenäyttelyissä ja bongailla lintuja. Fuksivuonna tykkäsin eniten kaikenlaisista sitseistä :)


Hellou <3 Olen Polina ja minut löytää kuvasta oikealta! Eka opiskeluvuosi molella on ollut ihanaa ja lempikurssini olivat genetiikan perusteet, solubilsa ja immunobilsa :] Olen aikatauluttamisen final boss ja arkeni koostuu DnD peluusta, erinäisistä töistä, lukemisesta, grafiikkojen luomisesta opiskelijajärjestöille ja spekseilystä. Kesällä lomailin peheeni kanssa viikon Latviassa, juoksin kantakaupungin rantareitin, erakoiduin kotikylääni pariksi viikoksi ja selvisin kahdesta työstä banaanikärpästen ja videoeditoinnin parissa! Fuksivuoteni oli täynnä yllättäviä käänteitä ja henkeäsalpaavia kokemuksia ja toivon teille yhtä ihanaa ja unohtumatonta opintojen alkua!
Moii!! Mä oon Anniina, tokan vuoden moleopiskelija. Fuksivuonna viihdyin opinnoissa, sain ihania ystäviä ja rakastuin Viikkiin, missä maisemat muistuttaa kotikulmia Hattulan maaseudulla. Vapaa-ajalla mut löytää todennäköisesti lukemasta, treenaamasta, kirjoittelemasta tai eräilemästä jossain luonnon helmassa. Tänä kesänä tein töiden kautta uuden aluevaltauksen melonnan parissa Itä-Helsingin saaristo on mieletön! Molella mun lempikursseja on olleet immunobilsa sekä tietenkin labrat.
Me saatiin toisistamme hyvät ystävät heti opintojen alkutaipaleella, ja jaetaan lämpimät muistot meidän orientaatioviikosta ja fuksisyksystä kokonaisuudessaan. Lähdettiin tuutoreiksi, koska halutaan tarjota teille yhtä hieno startti yliopistoelämään, ja toisaalta on kivaa päästä tunnelmoimaan siivellä :p Haluamme taata, että jokainen kokee olonsa tervetulleeksi ja turvalliseksi, vaikka opintojen alkuun liittyykin tervettä jännitystä. Meihin voi olla vaikka heti yhteydessä matalalla kynnyksellä mihin tahansa liittyen. Odotetaan jo innolla, että tavataan!


Hei! Oon Jenica, toisen vuoden opiskelija molella. Alun perin oon lähtöisin Kemistä, mutta nyt jo useamman vuoden asunut pääkaupunkiseudulla. Ekan vuoden opinnoissa kiinnostavimmat kurssit olivat genetiikan perusteet ja erityisesti mikrobiologian labrakurssi! Vuoteen mahtui erilaisten kurssien lisäksi paljon tapahtumia, kuten sitsejä, approja ja tietenkin vappuviikko. Yleisesti on tullut opittua paljon uutta, aina labratyöskentelystä koodaamisen alkeisiin. Opintojen ulkopuolella luen kirjoja, pelaan tietokonepelejä, vietän aikaa kavereiden kanssa tai chillailen kotona kissojen ja avopuolisoni kanssa.
Moikka! Mä oon Sofia ja alotin juuri tokan vuoden molella. Kotoisin oon Hyvinkäältä ja nykyään asustan Vantaalla bussimatkan päässä koulusta. Molella oon hurahtanut solubiologiaan ja genetiikkaan, ja opiskelu ekana vuonna olikin erittäin mielenkiintoista ja sain oppia paljon kaikkea kivaa. Vapaa-ajalla tykkään käydä keikoilla tai sitten vaan oleskella mun kissan kanssa, leffoja kattoessa tai kirjoja lukiessa.

Tutustuimme orientaatioviikolla, kun tiemme olivat johtaneet samaan fuksiryhmään. Orientaatioviikolla äärimmäinen kilpailuhenkisyys toi meitä yhteen ja sen viikon jälkeen ollaankin puuhailtu paljon yhdessä. Vuoden aikana käytiin yhdessä tapahtumissa, tuskailtiin koulutehtävien kanssa, oltiin labrapari ja lopulta sitten meistä tuli tuutorpari!
Heippa uudet fuksit ja tervetuloa molelle! Ollaan tuutorikolmikko ja tavattiin toisemme fuksivuoden orientaatioviikolla.
Mä oon Anni ja teidän tuleva tuutori. Oon alunperin Hämeenlinnasta kotosin ja muutin vuos sitten molen perässä tänne Helsinkiin. Sillon kun en oo kirjastossa opiskelemassa niin mut voi löytää salilta tai kotoa lukemasta. Tykkään myös fudiksesta ja kavereitten kanssa hengaamisesta. Molella mua kiinnostaa erityisesti genetiikka ja kehitysbilsa ja ootankin jo innolla tulevan vuoden kursseja, joihin lukeutuu muun muassa geenitekniikan labra. Paljon onnee opiskelupaikasta, syksyllä nähdään!
Moi! Mä olen Hanna ja mulla on nyt vuosi molella opiskelua ja Helsingissä asumista takana. Mole ja Helsinki on yllättänyt mut positiivisesti, ja oon erityisesti kiinnostunut tällä hetkellä neurotieteistä ja tutkijan alasta. Opiskelun lisäksi muo kiehtoo seikkailut, Ihmiset, luonto ja kulttuuri. Mun moniin harrastuksiin kuuluu muun muassa kahviloissa istuminen (ja työskentely) sekä yksin reissaaminen. Ihana päästä tutustumaan teihin!
Moikka! Mä olen Heta ja mulla myös alkaa nyt toinen vuosi molella. Opiskelun lisäksi teen töitä taitouintivalmentajana ja käyn itsekin silloin tällöin uimassa tai salilla. Vapaa-ajalla tykkään myös matkustaa ja hengailla kavereiden kanssa. Molella mua kiinnostaa melkein kaikki, mutta 1. vuoden kursseista pidin eniten kemian kursseista ja labroista. Tykkäsin myös tilastollisen laskennan perusteet -kurssista ja siitä innostuinkin ohjelmoinnista. Odotan innolla, että pääsen tutustumaan teihin uusiin fukseihin orientaatioviikolla!

Moi, me ollaan Toma ja Ella! Vaikka aloitettiin eri tuutori ryhmissä tutustuttiin jo heti pre-orientoivan päivän jatkoilla. Orientaatioviikolla Toma ”adoptoitiin” Ellan ryhmään, jonka jälkeen ollaan oltu aika lailla yks isompi kaveriporukka. Jos tästä jotain siis voi oppia, niin älkää stressatko kyllä ne kaverit jostain löytyy! Ja hei, muistakaa että kaikki me tuutorit ollaan oltu fukseja, joten älkää epäröikö kysyä niitä tyhmiltä tuntuvia kysymyksiä, lupaan että ollaan kysytty vähintäänkin yhtä tyhmiä juttuja. Me ollaan täällä auttamassa ja tukemassa teitä. Odotetaan innolla, että päästään tutustumaan teihin kaikkiin paremmin!
Moikka! Oon Ella ja molelle tulin avoimen kautta, kun fyssarin ammatti ei riittäny. Tällä hetkellä toimin Helixin hallituksessa tiedottajana, eli jos postauksissa on jtn epäsoveliasta, no comment :). Opinnoissa erityisesti kiinnostaa neurotieteet, molen kursseista lemppari on ollut Geenit ja yksilönkehitys (eli GJYK, kuulemma molen (melkein) vaikein kurssi). Oon kotoisin täältä Helsingistä, joten jos eksytte soita, tekstaa, laita mulle viestii!
TG: ellariikka
Moikka! Oon Toma yks tän vuoden tuutoreista. Löysin molen sattumalta ja pääsinki pääsykokeella sisään. Mua on kiinnostanu opinnoissa genetiikka ja varsinki oon pitäny labrakursseista. Oon Vaasasta kotosin ja asunu täällä pian vasta vuoden. Väitin aina, etten ikinä muuta Helsinkiin, mutta tänne mä sit päädyin :). Jos tarviitte apua tai tukea, nii ottakaa vaan vapaasti yhteyttä.
TG: tomaelias


Moi! Oon Annika ja kotoisin Vantaalta, mutta nykyisin asun lähempänä Viikkiä Helsingissä. Vapaa-ajalla tykkään urheilla ja kokeilla eri lajeja laidasta laitaan. Harrastin pitkään joukkuevoimistelua, mutta nyt etsin itselleni jotain uutta harrastusta :D Urheilun ja opiskelun lisäksi oon käyny monissa opiskelijatapahtumissa, joista sitsit ja vappu oli ensimmäisen vuoden ykkösjuttuja. Orientaatioviikko oli mahtavaa aikaa tutustua uusiin ihmisiin ja löytää opiskelukavereita. Kiireisen arjen keskellä on kuitenkin parasta vaan rentoutua kotona ja pelailla vaikka lautapelejä kavereiden kanssa.
Molen ensimmäinen vuosi sisälsi monia mielenkiintoisia kursseja, ja mun lemppariaiheita oli genetiikka, immunobiologia ja solubiologia. Teoriaopintojen lisäksi oon nauttinut labrakursseista, joissa pääsee soveltamaan opittua teoriaa käytännössä.
Morjens! Oon Mikael, tuttavallisemmin Mikke. Oon erityisen kiinnostunu neurotieteistä ja kaikesta aivoihin ja elämään liittyvästä. Kesää oon viettäny lähinnä urheilun, opintojen ja olympiakoripallon merkeissä. Lähellä mun sydäntä on ehdottomasti myös musiikki, donitsit, ja keuhkot (haha).
Mun fuksivuosi alko ryminällä, kun heti syyskuussa lähin Köpiksee mukaan PM-kisoihin (pohjoismainen urheilutapahtuma, josta voi tulla kyselemään lisää). Opintojen ohessa tuli käytyä kaikenlaisissa muissaki tapahtumissa, jotka on kyl ollu mainio piristys hommien keskellä.
Tosi monipuolisesti sai ekana vuonna opiskella erilaisia kursseja, joista mun lemppareiks nous ehdottomasti solubiologia, genetiikka ja eläinfysiologia. Fuksivuosi oli kokonaisuudessaan mahtava, joten lähen innolla kohti uusia koitoksia.

Me tutustuttiin orientaatioviikolla, sillä oltiin samassa tuutoriryhmässä. Fuksivuosi meni tosi nopeasti ja ollaan tutustuttu vuoden aikana moniin mahtaviin ihmisiin. Tuutoreina halutaan tarjota teille ikimuistoinen fuksisyksy ja parhaat mahdolliset eväät opintojen aloittamiseen. Onnea kaikille opiskelupaikasta molella ja tsemppiä tuleviin opintoihin! Nähdään pian pre-orientoivassa päivässä ja orientaatioviikolla <3
Moikka! Me ollaan tuutoritrio Aino, Eini ja Kaisa (kuvassa oikealta vasemmalle). Huippua, että oot ottanut opiskelupaikan vastaan molelta ja lämpimästi tervetuloa Viikkiin! Odotetaan jo innolla teidän uusien fuksien tapaamista ja orientaatioviikon meininkejä, ja itseasiassa sieltä meidänkin ystävyys alkoi, vaikka oltiinkin eri fuksiryhmissä. Vaikka alkuun kaikki tuntuisi tosi sekavalta, niin me ollaan täällä teitä varten ja lyödään kolme viisasta päätämme yhteen, jotta osataan auttaa teitä parhaamme mukaan kaikissa mieltä askarruttavissa asioissa. Ollaan kaikki muutettu vuosi sitten koulupaikan perässä eri puolilta Suomea Helsinkiin eli meiltä saa vertaistukea ja vinkkejä myös mm. sanojen ”Steissi” ja ”spora” sisällyttämiseksi sanavarastoon (lisää uskottavuutta merkittävästi). Kaisalta ja Einiltä voi lisäksi kysellä kaksikielisistä TvEx-opinnoista. Och samma på svenska…!
Moi, mää oon Aino! Oon pohjimmiltani ylpeä oululainen. Mun mielestä ehdottomasti parasta elämässä on matkustaminen ja vuorimaisemissa patikoiminen. Eka vuosi molella tuli ja meni ihan super nopeasti ja nyt on ihanaa aloittaa toka vuosi teidän uusien fuksien kanssa. <3 Fuksivuosi oli täynnä ihania ihmisiä ja kiinnostavia kursseja. Solubiologia oli erityisen kiinnostavaa. Mulla on tosi hyvä fiilis tulevasta syksystä - toivottavasti teilläkin!
Moikka! Mä oon Eini, nykyisin helsinkiläinen mutta sydämeltäni savolainen eli siis kotoisin Kuopiosta. Erityisesti ekan vuoden opinnoissa tykkäsin siitä, että pääsi tutustumaan monipuolisesti eri aihealueisiin ja omia lemppareita onkin ollut genetiikka sekä fysiologia. Opiskelijaelämän ulkopuolella viihdyn jooga- ja pilatestunneilla sekä ihan vaan ystävien kanssa hengaillessa. Ps. Ei stressiä, lupaan että en aio kysyä teidän toteemieläintä tai hauskaa faktaa itsestänne :D
Heips! Mä oon Kaisa, Jyväääskylästä lähtöisin, eikä musta pitänyt tulla helsinkiläistä. Päädyin molelle vähän kokeilumielessä ettimään omaa juttua ja yleensä opinnoista kysyttäessä vastaankin, että ”ei oo tyhmää”. Erityisen ei-tyhmiä juttuja tähän mennessä on olleet mm. fysiologiaan ja genetiikkaan liittyvät asiat sekä kaikki huipputyypit, joiden kanssa jakaa (epä)onnistuneimmat labrahetket yms. Opiskelun vastapainoksi mua innostaa monenlainen liikunta aina tanssista jalkapalloon, mutta viihdyn myös kirja tai virkkuukoukku kädessä kotona. Antoisaa syksyä just sulle! :)

Tutkimuksen ja opetuksen lisäksi olen toiminut fysiologian opintoneuvojana ja vastaan nyt kysymyksiin koskien neurotieteiden suuntautumisvaihtoehtoa. Olen myös perillä kandin perusrakenteesta ja vähän kaikesta muustakin, eli jos jokin askarruttaa niin ota rohkeasti yhteyttä!
Tällä hetkellä minut saa varmimmin kiinni soittamalla, mutta voit ottaa yhteyttä myös sähköpostitse. Kampuksella voit myös tulla koputtelemaan biokeskus 3, toisen kerroksen huoneeseen 2711!
Voidaan myös sovittaessa tavata zoomissa! Jag är finlandssvensk så att träffas på svenska går bra!
Jos liikut Pohjois-Norjassa heinäkuussa, saatat löytää minut jonkin lohijoen äärestä!
Tieteenala/neuvonnan vastuualue
Fysiologia ja neurotiede.
Huoneen numero ja sijainti
Biokeskus 3, huone 2711, 2. kerros.
Yhteystiedot mikael.segerstrale@helsinki.fi 0294159826
Millä tavalla sinuun saa parhaiten yhteyttä? Puhelimitse, ellen vastaa niin tekstiviestillä tai sähköpostilla.
Miksi biotieteet ovat parasta ikinä? Ei sitä muuta tarvitse osata.


Aloitin opiskelut Helsingin yliopistolla 2001 ja suoritin sekä graduni että väitöskirjani molekyylivirologian alalta, tutkien virusperäisten RNA-riippuvaisten RNA-polymeraasien toimintaa. Väitöksen jälkeen vaihdoin tutkimussuuntaa ja tein proteiinisynteesin säätelyyn liittyvää postdoc-tutkimusta Max Planck Institute for Molecular Biomedicine:ssa Münsterissä Saksassa. Palattuani Suomeen perustin syyskuussa 2016 oman tutkimusryhmän. Tutkimuksemme tavoitteena on selvittää miten RNA-emäsmuokkaukset vaikuttavat proteiinisynteesiin ja sen säätelyyn niin infektion, syövän muodostuksen ja muiden fysiologisten stressitekijöiden aikana. Tutkimme myös miten RNA-emäsmuokkauksia voidaan hyödyntää eri bioteknologisissa sovelluksissa esim. proteiinituoton tehostamiseksi.
Tieteenala/neuvonnan vastuualue Mikrobiologian ohjaava opettaja biologian koulutusohjelman opiskelijoille.
Huoneen numero ja sijainti
Biokeskus 1, B-porras, 6. kerros, huone 6213.
Yhteystiedot peter.sarin@helsinki.fi 0294159533
Millä tavalla sinuun saa parhaiten yhteyttä? Ehdottomasti sähköpostitse. Työpuhelimeen tulee vastattua jos akussa on virtaa.
Miksi biotieteet ovat parasta ikinä? Jatkuva löytämisen ja oppimisen ilo. Kuten tieteessä monesti, mitä enemmän tutkimme tiettyä asiaa, sitä enemmän opimme siitä ja sitä enemmän tiedostamme kuinka rajallinen meidän ymmärrys oikeasti on ja miten paljon uuttaa tutkittavaa on vielä edessämme.
Riitta Savolainen

Akateeminen opintopolkuni alkoi 1979, kun pääsin Helsinkiin opiskelemaan biologiaa. Opintojen ensimmäinen vuosi oli kuitenkin niin tylsä – ekana syksynä ei muistaakseni ollut lainkaan biologiaa – että lähdin helmikuussa 1980 ystäväni kanssa koko kevääksi Norjaan kalatehtaalle töihin. Palasin Norjasta suoraan Lammin biotooppijaksolle. Sitten pääsin opiskelussa vauhtiin. Tein graduni 1984 muurahaisyhteisöistä Tvärminnessä. Sen jälkeen keräsin putkeen seuraavat viisi kesää aineistoa Tväminnen muurahaisista väitöskirjaani, joka valmistui 1989. Väittelyn jälkeen postdokkasin useita vuosia Kanadassa (U of Alberta), USA:ssa (Harvard), Japanissa (Tokyo Metropolitan U), USA:ssa (Smithsonian). Palasin kotiin, jossa työttömänä, mutta pian kuitenkin sain opetushommia, tein tutkimusta, johon sain jopa välillä tutkimusrahaakin. Nyt suunnittelen porukalla uutta biologian kandiohjelmaa eli biokandia, jonka rakenteessa näkyy vielä valitettavan paljon vanhoja laitosrakenteita, kun opiskelijan pitäisi olla keskiössä.
Tieteenala/neuvonnan vastuualue
Biologian kandiohjelman ohjaava opettaja. Ohjaan yleisesti kandiopintoja ja erityisesti ekologian ja evoluutiobiologian tieteenalan opintoja.
Huoneen numero ja sijainti Biokeskus 3, huone 5416, 5. kerros.
Yhteystiedot riitta.savolainen@helsinki.fi 0504155290
Millä tavalla sinuun saa parhaiten yhteyttä? Ehdottomasti sähköpostitse.
Miksi biotieteet ovat parasta ikinä?
Tästä olen eri mieltä, sillä voisin tehdä monia muitakin asioita.
Olen Saija, translationaalisen kasvitieteen apulaisprofessori. ”Translationaalinen” tarkoittaa tutkimusta, joka tähtää perustutkimuksesta saadun tiedon hyödyntämiseen käytännön sovelluksissa. Taustani on kasvien fotosynteesin ja valosopeutumisen tutkimuksissa. Tätä osaamista hyödynnämme nyt pienoiskasvihuoneviljelyn kehittämisessä. Jospa vaikka lehtikaali saataisiin erilaisia valo-ohjelmia käyttäen maistumaan makealta kuin kehittyvä herneenpalko!
Vapaa-aikanani harrastan pyöräilyä ja puutarhaa. Ja tietenkin näiden vastapainona grillausta ja rentoa oleilua hyvässä seurassa.
Tieteenala/neuvonnan vastuualue Kasvitiede.
Huoneen numero ja sijainti Biokeskus 3, 6. krs, huone 6712.
Yhteystiedot saijaliisa.kangasjarvi@helsinki.fi +358 50 4647088
Millä tavalla sinuun saa parhaiten yhteyttä?
Sähköpostilla. Jos olen paikalla lämpimästi tervetuloa työhuoneelleni jos ovi on auki! (Tärkeän Zoom-kokouksen ajan ovi on kiinni).
Miksi biotieteet ovat parasta ikinä?
Biotieteet tarjoavat huimaavan määrän kysymyksiä, joihin meillä ei vielä ole vastauksia. Selvittämällä elämän ihmeitä voimme kehittää ympäristöystävällisiä ja kestäviä sovelluksia yhteiskuntamme hyväksi.


Olen perinnöllisyystieteen yliopistonlehtori.
Opetan genetiikan perusteita, sytogenetiikkaa ja ihmisgenetiikkaa ja ohjaan ihmisgenetiikkaan liittyviä kanditutkielmia, myös ruotsiksi. Koordinoin myös sairaalageneetikon koulutusta (jatkotutkinto). Tutkin perinnöllisiä lihastauteja, etenkin synnynnäisten myopatioiden molekyyligenetiikkaa. Tutkimusryhmäni toimii Biomedicumissa Meilahden kampuksella. Toimin myös Viikin ja Meilahden kampusten tutkimusetiikan tukihenkilönä.
Tieteenala/neuvonnan vastuualue
Perinnöllisyystiede. Genetiikan ohjaava opettaja biologian kandiohjelmassa ja GMB-maisteriohjelmassa.
Huoneen numero ja sijainti
Biokeskus 1, C-porras, 3.kerros, huone 3314.
Yhteystiedot katarina.pelin@helsinki.fi 050 4485651
Millä tavalla sinuun saa parhaiten yhteyttä?
Ehdottomasti sähköpostitse, pyrin vastaamaan viesteihin nopeasti.
Miksi biotieteet ovat parasta ikinä?
Biotieteet ja luonnontieteet antavat kokonaisvaltaisen tieteelliseen tutkimukseen perustuvan maailmankuvan. Biotiede auttaa meitä ymmärtämään pandemioiden ja ilmastonmuutoksen syntymekanismeja ja miten niitä kannattaisi torjua. Biotieteellinen perustutkimus on myös aivan oleellinen uusien lääkkeiden, rokotteiden ja diagnostiikan kehitystyössä.
Janne Ravantti
Tieteenala/neuvonnan vastuualue Tieteellinen laskenta ja bioinformatiikka.
Huoneen numero ja sijainti 3403.1, Bio1, 3. krs.
Yhteystiedot janne.ravantti@helsinki.fi 0294125513
Millä tavalla sinuun saa parhaiten yhteyttä? Sähköposti, ehdottomasti!
Miksi biotieteet ovat parasta ikinä?
Donald E. Knuthin sanoin: ”I can’t be as confident about computer science as I can about biology. Biology easily has 500 years of exciting problems to work on, it’s at that level.”
Benita Westerlund-Wikström
Tieteenala/neuvonnan vastuualue Mikrobiologia / molekyylibiotieteet.
Huoneen numero ja sijainti 2314, Biokeskus 1, 2C-kerros.
Yhteystiedot benita.westerlund@helsinki.fi 050 4150429
Millä tavalla sinuun saa parhaiten yhteyttä? S-postitse.
Miksi biotieteet ovat parasta ikinä?
Ne liittyvät elämän kaikkiin ulottuvuuksiin ja niistä oppii koko ajan uutta. En voisi ajatella muuta alaa.

Kristiina Mäkinen
Tieteenala/neuvonnan vastuualue
Biokemia / Molekyylibiotieteiden kandiohjelma HOPS-ohjaus minulle nimetyille opiskelijoille, kanditöiden ohjausta omalta tieteenalalta (kasvibiologia, virologia).
Huoneen numero ja sijainti
Biokeskus 1, huone nro 3011 (Mikrobiologian osasto, MMTDK).
Yhteystiedot
kristiina.makinen@helsinki.fi 294158411
Millä tavalla sinuun saa parhaiten yhteyttä?
Kysymykset ja tapaamisajan varaukset sähköpostilla.
Miksi biotieteet ovat parasta ikinä?
Olen tänä päivänä yhtä innostunut kuin aikoinaan opiskelijana tutkimaan kasvien virustauteja. Onnistuneen tutkimuksen ytimessä ovat opiskeluaikana saadut tiedot biomolekyylien ominaisuuksista, solun toiminnasta sekä vahva laboratorio-osaaminen. Inspiroidun myös seuratessani muiden tieteenalojen huippututkimusta siitä, miten tarkoituksenmukaisesti ja tarkasti säädellysti solut toimivat.

Anne-Maria Pajari

Tieteenala/neuvonnan vastuualue MOLE-kandiohjelma on neuvonnan vastuualue, mutta tutkimukseni tieteenala on molekulaarinen ravitsemustiede.
Huoneen numero ja sijainti
Huone 2039, EE-talo, 2 krs. Agnes Sjöbergin katu 2.
Yhteystiedot anne-maria.pajari@helsinki 0294158203
Millä tavalla sinuun saa parhaiten yhteyttä?
Parhaiten saa yhteyttä sähköpostitse.
Miksi biotieteet ovat parasta ikinä?
Biotieteet tarjoavat hyvän pohjan monenlaisiin maisteriohjelmiin, joiden puitteissa pääsee syventymään vaikkapa molekulaariseen ravitsemustieteeseen.
Minna Poukkula
Tieteenala/neuvonnan vastuualue
Solu- ja kehitysbiologia.
Huoneen numero ja sijainti
Biokeskus 2, rappu D, huone 2018b.
Yhteystiedot
minna.poukkula@helsinki.fi 0294159722
Millä tavalla sinuun saa parhaiten yhteyttä?
Sähköpostitse.
Miksi biotieteet ovat parasta ikinä?
Biotieteet antavat ymmärrystä siihen miten me ja meitä ympäröivä elollinen maailma toimii. Alan opiskelu ja tutkimus antavat hienoja ahaa-elämyksiä kun molekyylitason yksityiskohdat loksahtelevät kohdalleen suuremmiksi kokonaisuuksiksi ja kun ensimmäistä kertaa ikinä näkee jotain, mitä kukaan muu ei ole nähnyt aikaisemmin! Ehkä kuitenkin yksi parhaista asioista biotieteissä on se yhteisö jonka me biotieteilijät rakennamme yhdessä, itse olen tästä joukosta löytänyt lähimmät ystäväni, joista osa asuu toisella puolella maailmaa. Toivotan teidät lämpimästi tervetulleeksi opiskelemaan biotieteitä ja mukaan tähän yhteisöön!
Tieteenala/neuvonnan vastuualue
Biokemian yliopistonlehtori, virustutkija.
Huoneen numero ja sijainti
Biokeskus 1, 3011.
Yhteystiedot tero.ahola@helsinki.fi 0294159403
Millä tavalla sinuun saa parhaiten yhteyttä? Olen usein paikalla huoneessani (ei ajanvarausta) tai sähköpostilla.
Miksi biotieteet ovat parasta ikinä?
Biotieteet selittävät elämän molekyylitason toiminnan.

Tieteenala/neuvonnan vastuualue Mikrobiologia, sienitiede.
Huoneen numero ja sijainti Biokeskus 1, huone 3007.
Yhteystiedot sari.timonen@helsinki.fi
050 448 5965
Millä tavalla sinuun saa parhaiten yhteyttä? S-postilla tai kysymällä huoneesta.
Miksi biotieteet ovat parasta ikinä?
Niiden avulla ymmärtää miksi ja miten eliöt ovat olemassa ja vuorovaikutuksessa.
Tieteenala/neuvonnan vastuualue
Mikrobiologia ja biotekniikka. Minut tapaa ainakin molen biokemian ja mikrobiologian peruslaboratoriotöissä.
Huoneen numero ja sijainti Biokeskus 1, huone 3007.
Yhteystiedot
pauliina.lankinen@helsinki.fi 0504151684
Millä tavalla sinuun saa parhaiten yhteyttä?
Minut saa kiinni parhaiten sähköpostitse. Ja aina kannattaa kurkata huoneen 3007 ovesta, jos Viikissä olet ja haluat sopia tapaamisen.
Miksi biotieteet ovat parasta ikinä?
Biotieteilijänä ymmärrät miten luonto toimii ja osaat kertoa sen myös muille!

Tieteenala/neuvonnan vastuualue
Tieteenalani on lähinnä kotieläingenetiikkaa ja biotekniikkaa. Neuvon molekyylibiotieteiden kandiohjelman lisäksi maataloustieteiden maisteriohjelman opinnoista kiinnostuneita.
Huoneen numero ja sijainti Koetilantie 5, huone 208.
Yhteystiedot
kari.elo@helsinki.fi 0294158544
Millä tavalla sinuun saa parhaiten yhteyttä?
Sekä puhelimella että sähköpostilla.
Miksi biotieteet ovat parasta ikinä?
Biotieteet auttavat ratkomaan ihmiskunnan suuria haasteita.


24.8. Preorientoiva päivä Suomenlinnassa
26.–30.8. Orientaatioviikko
13.–15.9. Kolmen kunnan ralli
27.9. BD-pelit
4.10. Fuksisitsit
Preorientoiva päivä Suomenlinnassa Yhteislähtö Kauppatorilta
Tule tutustumaan opiskelukavereihin ja tuutoreihin ennen orientaatioviikkoa! Bio- ja ympäristötieteellisen tiedekunnan uudet opiskelijat ja tuutorit viettävät yhdessä päivää Suomenlinnassa piknikin merkeissä. Kysy lisää tietoja omalta tuutoriltasi.
Nähdään Suomenlinnassa!